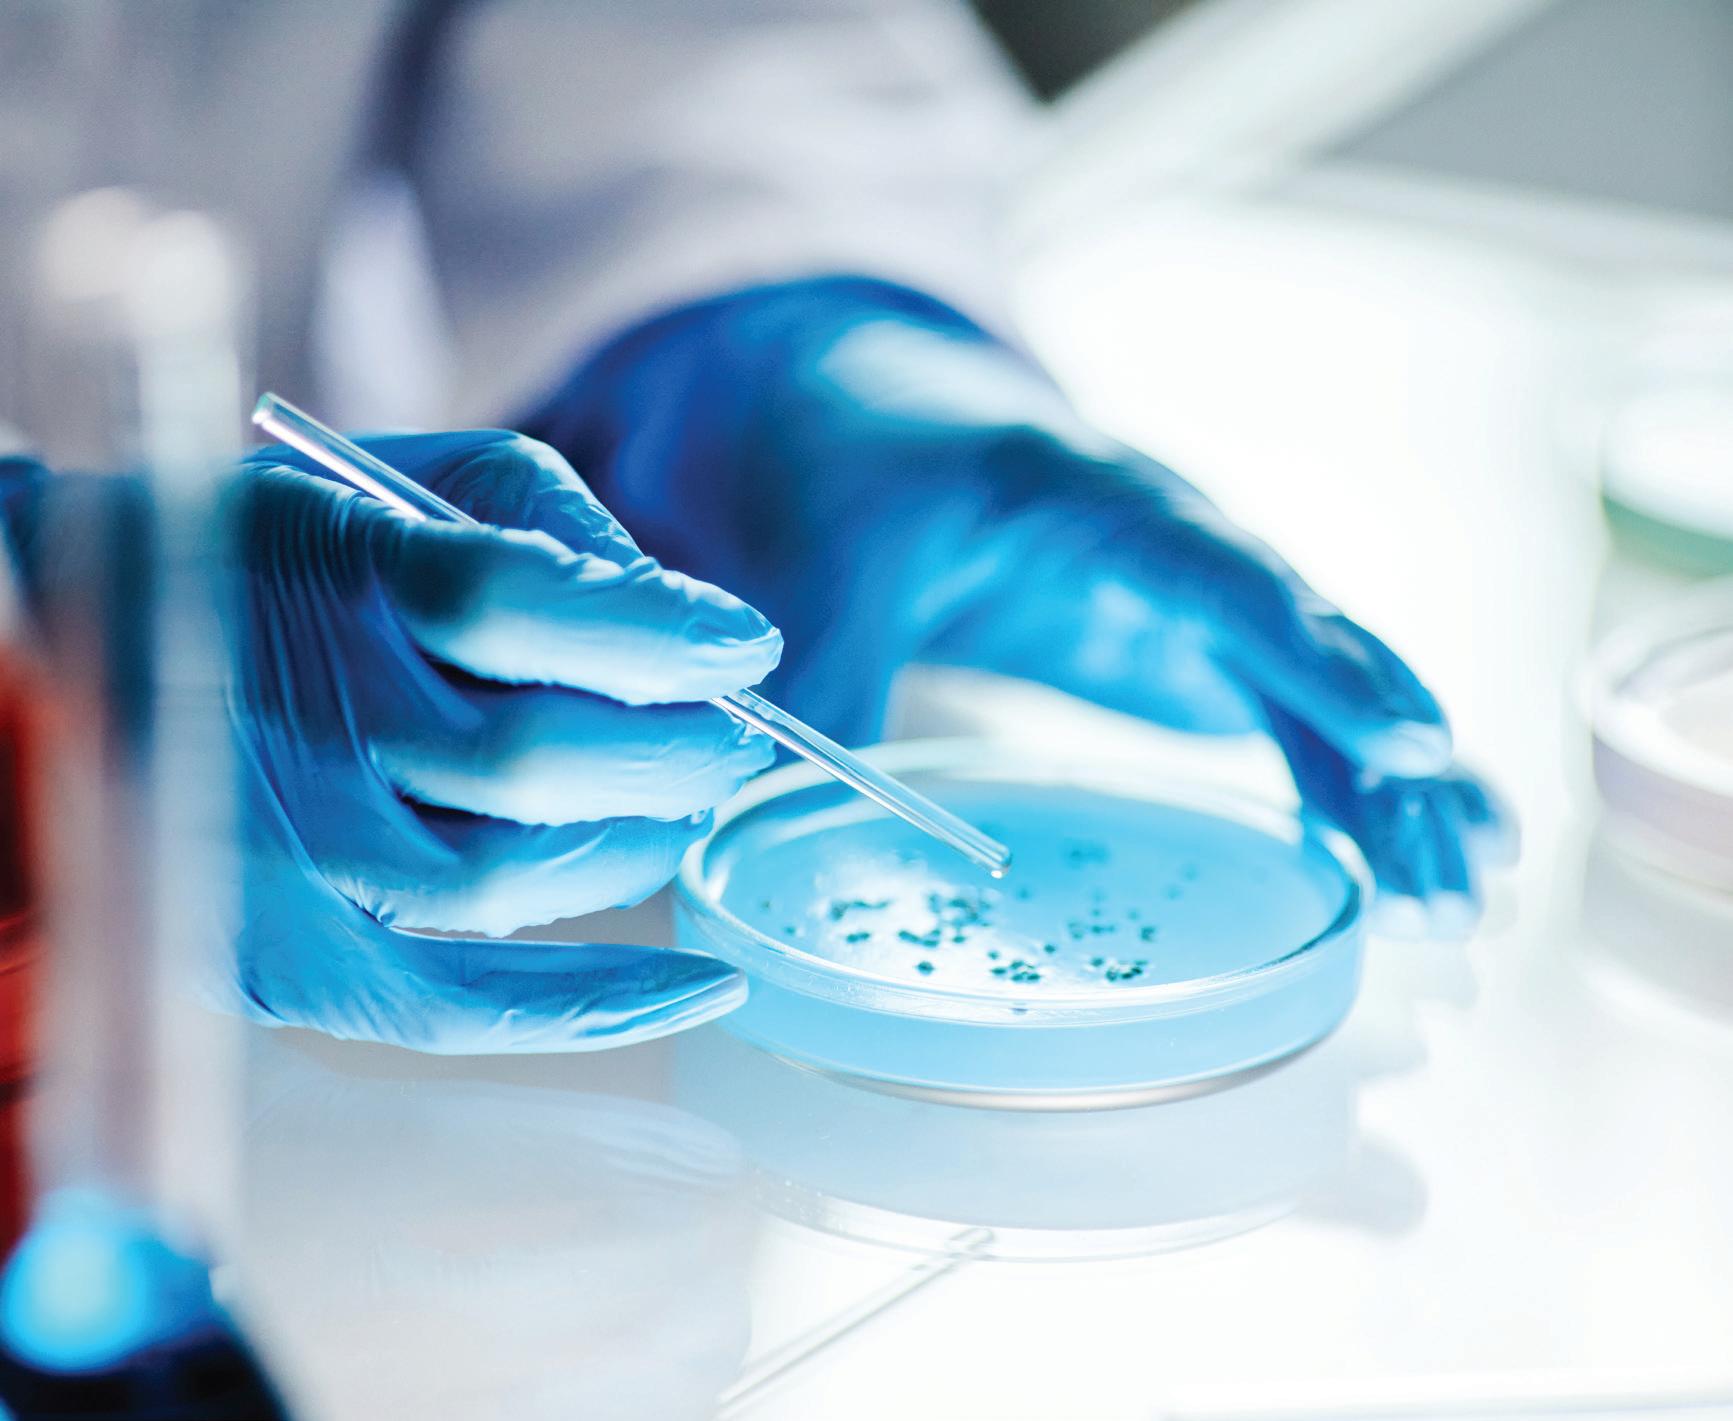

Bettina Husemann
Ob als Kind am Familientisch, als Jugendliche:r im Schulstress oder als Senior:in im Altersheim: Essen bedeutet viel mehr als nur Energiezufuhr. Es steht für Erinnerung, Trost, Zugehörigkeit, Freude und Genuss. Die Ernährungspsychologie untersucht unter anderem, wie Erfahrungen, Emotionen und soziale Kontexte unser Essverhalten prägen – oft unbewusst, aber mit grosser Wirkung. Dieses Wissen eröffnet neue Ansätze für die Gesundheitsförderung in jeder Lebensphase.
Eine Freundin hat mir kürzlich erzählt, wie sehr sie der Duft von frischen Kartoffelrösti an ihre Kindheit erinnert. Jeden Freitag bereitete ihre Grossmutter ihre legendären Rösti zu. Und noch heute gibt ihr dieser Duft ein Gefühl von Geborgenheit. Solche Erfahrungen prägen unser Essverhalten oft stärker, als uns bewusst ist. Die Ernährungspsychologie hilft uns zu verstehen, warum das so ist – und wie wir dieses Wissen für die Gesundheitsförderung in allen Lebensphasen nutzen können.
Kindheit: gesunde Gewohnheiten wachsen lassen
Bereits in den ersten Lebensjahren sammeln Kinder Erfahrungen rund ums Essen. Diese können ihr späteres Essverhalten mitprägen. Besonders wichtig ist dabei das Vorbild der Bezugspersonen. Wie diese mit Essen umgehen, beeinflusst Kinder nachhaltig. Rituale, gemeinsame Mahlzeiten, das Kennenlernen von neuen Lebensmitteln, das spielerische Erleben von Geschmack und Struktur sowie die Freude am Ausprobieren spielen dabei eine bedeutende Rolle. Dabei lernen Kinder nicht nur, was gesund ist, sondern auch, wie sich Hunger und Sättigung anfühlen und wie sich die Ernährung auf das eigene Wohlbefinden auswirkt.
Essen ist nicht nur «Pflichtaufgabe» oder Versorgung mit Nährstoffen. In Kindertagesstätten, Schulen und Familien kann eine Esskultur entstehen, die gesunde Gewohnheiten nicht aufzwingt, sondern wachsen lässt. Der Genuss steht dabei im Vordergrund – denn nur was Freude macht, bleibt langfristig im Alltag verankert.
Jugend: zwischen Gruppendruck und Selbstfindung
Die Jugend ist eine herausfordernde Phase: Identitätssuche, Körperbild, der Einfluss sozialer Medien. Essen kann dabei zum Ausdruck von Selbstbestimmung oder Anpassung werden. Wichtig ist, Jugendliche ernst zu nehmen und positive Vorbilder zu stärken.
In dieser Lebensphase stehen – was das Ernährungsverhalten betrifft – emotionale Bedürfnisse, soziale Zugehörigkeit und das Streben nach Autonomie

besonders im Vordergrund. Ein Snack kann Trost spenden oder Zugehörigkeit signalisieren.
Wer Jugendliche begleiten will, muss ihre Lebensrealität verstehen. Sie stehen heute unter hohem Leistungsdruck, sind stark durch soziale Normen geprägt und orientieren sich an schnell wechselnden Trends, insbesondere in den sozialen Medien. Das hat auch Auswirkungen auf ihr Essverhalten – und zeigt, wie wichtig es ist, ein positives Körperbild, Selbstvertrauen und psychosoziale Ressourcen zu stärken.
Partizipative Ansätze, also die aktive Einbindung Jugendlicher in gesundheitsfördernde Massnahmen, können ihre Motivation fördern und die Wirksamkeit der Angebote erhöhen. Schulen und Ausbildungsbetriebe spielen eine zentrale Rolle dabei, gemeinsam mit Jugendlichen gesunde Routinen zu entwickeln und diese im Alltag zu verankern.
Erwachsenenalter: zwischen Autopilot und Achtsamkeit Stress, Zeitdruck, Familie, Beruf – viele Erwachsene essen nebenbei oder aus emotionalen Gründen. Das Wissen ist vorhanden, doch die Routinen überwiegen. Hier setzt die Gesundheitsförderung an: mit Programmen, die etwa Achtsamkeit und Struktur fördern. Auch das soziale Umfeld spielt eine Rolle für gesundes und genussvolles Essen.
Oft geht es im Alltag nicht darum, was uns guttut, sondern was gerade funktioniert. Die Ernährungspsychologie hilft dabei, solche Automatismen zu erkennen. Warum greifen wir zur Schokolade, wenn wir unter Stress stehen? Was bedeutet ein gemeinsames Abendessen für unser Wohlbefinden? Gesundheitsförderung bedeutet in diesem Kontext auch, Raum für Genuss und Bewusstsein zu schaffen. Dies kann in der Betriebskantine, durch Impulse im Hausarztgespräch oder in Form digitaler Angebote geschehen. Auch niedrigschwellige Massnahmen – wie der Zugang
zu gesunden Snacks oder inspirierenden Rezepten für den Alltag – können Veränderungen bewirken.
Alter: Genusspotenziale neu entdecken Ist es zu spät für Veränderung? Keineswegs! Auch im hohen Alter können Essgewohnheiten positiv beeinflusst werden. Geschmacksempfinden, Appetit und Mobilität mögen sich verändern, trotzdem kann auch im hohen Alter das Essverhalten positiv verändert werden.
Ernährung wird im Alter häufig unterschätzt. Dabei bedeutet sie mehr als nur die Deckung des Bedarfs: Sie steht für soziale Teilhabe, für Lebensqualität und für das Erleben von Selbstbestimmung. Eine warme Suppe im vertrauten Umfeld kann Lebensqualität bedeuten. Wenn Einsamkeit oder Einschränkungen zunehmen, sind kreative, alltagsnahe Lösungen gefragt, die auch kulturelle und biografische Prägungen respektieren.
Im höheren Alter lohnt sich ein genauer Blick auf Gewohnheiten – denn sie prägen den Alltag oft stärker als Wissen oder Absicht. Gesundheitsförderung kann hier ansetzen, ohne zu überfordern: durch kleine Impulse, die vertraute Routinen aufgreifen oder neu gestalten helfen. Mahlzeiten in Gemeinschaft, mobile Ernährungsberatung oder gezielte Unterstützung durch betreuende Angehörige sind nur einige Möglichkeiten, wie Veränderung gelingen kann.
Fazit: eine lebensphasenübergreifende Perspektive für die Praxis Die Ernährungspsychologie zeigt: Um Menschen in ihren Essgewohnheiten zu verstehen, müssen Gefühle, Bindung, Biografie und Kontext berücksichtigt werden. In allen Lebensphasen. Die Gesundheitsförderung gewinnt, wenn sie dieses Wissen systematisch nutzt – sei es in der Schule, im Betrieb, zu Hause oder im Pflegeheim. Essverhalten ist mehr als Nährstoffzufuhr. Es wird geprägt von Emotionen, Lebensgeschichte und dem sozialen Umfeld. Wenn wir dieses Wissen konsequent in die Praxis umsetzen, können wir nicht nur Krankheiten vorbeugen, sondern auch Autonomie, Lebensqualität und Freude fördern. Die Ernährungspsychologie bietet hierfür eine wertvolle Grundlage und ist eine Inspiration für eine Gesundheitsförderung, die die gesamte Lebenswirklichkeit des Menschen berücksichtigt. Bon appétit!
Text Bettina Husemann, Projektleiterin Ernährung, Gesundheitsförderung Schweiz
Lesen Sie mehr. 04 Volkskrankheiten 08 Holistische Gesundheit
10 Interview: Prof. Dr. Beatrice Beck Schimmer 14 Frauengesundheit 16 Die Wichtigkeit der Hand 18 Sportmedizin 22 Stammzellenbehandlung
Fokus Gesundheit.
Projektleitung
Egzon Alili
Country Manager Pascal Buck
Produktionsleitung
Nicolas Brütsch
Layout
Mathias Manner
Text
Aaliyah Daidi, Kevin Meier, SMA Titelbild
Universität Zürich; Frank Brüderli Distributionskanal Tages-Anzeiger
Druckerei DZZ Druckzentrum AG
Smart Media Agency. Gerbergasse 5, 8001 Zürich, Schweiz Tel +41 44 258 86 00 info@smartmediaagency.ch redaktion@smartmediaagency.ch fokus.swiss


Viele Frauen leisten viel. Bei der Betreuung von Angehörigen und Kindern genauso wie bei der Arbeit. Nicht wenige Frauen gehen dabei regelmässig über ihre Grenzen und vergessen vor lauter Care-Arbeit ihre eigenen Bedürfnisse. Das kann fatale Folgen haben: Die dauernde Überlastung begünstigt Angststörungen, Burnout, Depressionen und Schlafstörungen. Auch chronische Erschöpfung (Fatigue-Syndrom), Fruchtbarkeitsprobleme, Schilddrüsenerkrankungen sowie Menstruations- und Zyklusstörungen sind häufig die Folge chronischer Überlastung. Zu guter Letzt werden auch Magenschleimhautentzündungen, Reizdarm und Rückenschmerzen mit chronischer Überlastung in Verbindung gebracht. Damit es nicht so weit kommt, sollten sich Frauen, die beruflich oder privat stark gefordert sind, regelmässig eine Auszeit gönnen und sich vollständig erholen.
Doch das ist nicht immer ganz einfach. Denn klassische Ferien sorgen nicht selten für zusätzlichen Stress. Egal, ob mit der Familie, der Freundin oder dem Lieblingsmenschen: Viele Frauen können auch im Urlaub nicht vollständig abschalten, weil ständig Ansprüche an sie gestellt werden. Aus diesem Grund eröffnete im Waadtländer Jura vor 33 Jahren ein einzigartiges RevitalisierungsCenter für Frauen seine Türen. Das Revital ist eine Mischung aus Gesundheitszentrum, Hotel und Wellnessoase. Hier können sich erschöpfte, gestresste und überarbeitete Frauen zurückziehen und neue Energie und Lebenskraft tanken. Statt immer nur für andere da zu sein, werden sie im Revital von A bis Z verwöhnt. Auch der Stress, stets perfekt frisiert, gekleidet und geschminkt zu sein, fällt weg: Im Revital sind Frauen unter sich und Bademantel und Jogginghose sind an der Tagesordnung. Lediglich am Freitag, beim Gala Dinner, ist adrette Kleidung erwünscht.


Viel zur Erholung und zu einem neuen Körpergefühl trägt die einzigartige Entschlackungsküche bei. Im Revital geniessen die Gäste vegetarische Vollwertkost mit farbenfrohen Früchten, biologischem Gemüse und frischen Kräutern. Die hochwertigen Rohstoffe reinigen den Organismus und stärken die Widerstandskraft. Die Mahlzeiten schmecken nicht nur fantastisch – sie sehen auch fantastisch aus. Im Revital ist jeder einzelne Teller ein farbenfrohes, essbares Kunstwerk.
Pascale Pilloud, die Direktorin, hat das einzigartige Revital-Konzept in den vergangenen Jahren laufend weiterentwickelt und den Bedürfnissen moderner Frauen angepasst. Im Pauschalpreis sind vier Körpertherapien inbegriffen. Zum Beispiel Fussreflexologie, Lymphdrainage, Ortho-Bionomy®, Reiki, Shiatsu oder Körpermassage.
Ebenfalls inbegriffen sind drei kosmetische Behandlungen: Gesichtsbehandlung mit Handpackung, Ganzkörperpeeling mit Rückenmassage, Aroma-Leberwickel und Ohrenkerzen. Weitere Therapien und Behandlungen können jederzeit dazu gebucht werden. Wähle auf revital.ch dein persönliches Lieblingszimmer und reserviere deinen Erholungsurlaub noch heute. Wir freuen uns, dich eine Woche lang zu verwöhnen.

Herbstfarben wie aus dem Bilderbuch laden zu sanften E-Bike-Touren durch malerische Landschaften ein; wundervolle Thermal- und Wellness-Oasen locken mit wohliger Wärme für Körper und Seele. Die Wellness4-Tour kombiniert Naturschauspiel mit Thermalwasser zu einem perfekten Achtsamkeitserlebnis in vier Etappen. Auszeit geniessen, neue Energie tanken und dabei den Bäderkanton Aargau von seiner entspanntesten Seite kennenlernen: Willkommen im Aargauer Herbst!
Tour 1: Von Rheinfelden nach Bad Zurzach Als Erstes geht es vom idyllischen Städtchen Rheinfelden 54 Kilometer dem Rhein entlang Richtung Bad Zurzach. Hier winkt ein Besuch der grössten Freiluft-Therme des Landes: In sechs unterschiedlichen Becken erfreut man sich am vitalisierenden Thermalwasser aus der Glaubersalz-Quelle. Elf Saunen und einige Dampfbäder erweitern das ganzheitliche Wohlfühlerlebnis.

Tour 2: Von Bad Zurzach nach Baden Mit 19 Kilometern ist die zweite Etappe deutlich kürzer. Von Bad Zurzach aus führt die Tour ins Winzerdorf Tegerfelden, dann via Endingen in die Kultur- und Bäderstadt Baden. Dort steht am Limmatknie die eindrückliche Wellness-Therme FORTYSEVEN. Das mineralreichste Thermalwasser der Schweiz fliesst hier etwa in den grossen Outdoorpool, während der sogenannte Kosmos alle Sinne verzaubert mit seiner wärmenden Liegemuschel sowie Licht- und Toneffekten von Boris Blank.

Tour 3: Von Baden nach Schinznach-Bad Erholt steigen E-Bikerinnen und E-Biker am nächsten Tag wieder auf den Sattel. Bald treffen sie in Brugg auf historische Spuren der Römer und Habsburger. Danach ist Bad Schinznach mit der stärksten Schwefelquelle der Schweiz erreicht. Entspannt wird entweder im Thermalbad Aquarena fun oder in der Ruheoase Thermi spa. Auf insgesamt 1400 m2 Thermalwasserfläche und in den neun Saunen und Dampfbädern finden Gäste jeden Alters ein passendes Angebot.

Die Routen 56 und 2 von Schweiz Mobil bringen einen auf der vierten Etappe nach Rheinfelden zurück. Mit 50 Kilo-
Intensiv-Solebecken lockert die warme Rheinfelder Natursole® die strapazierten Muskeln und hilft, neue Kräfte zu sammeln.

Unterwegs mit dem Wellness Pass Genauso entspannt wie die Reise mit dem E-Bike durch die eindrucksvolle Aargauer Landschaft gestaltet sich mit dem Wellness Pass der Besuch der vier Thermal- und Wellnessbäder: Für 135 Franken bietet der Pass Gästen je einen Eintritt in Bad Zurzach, Baden, Bad Schinznach und Rheinfelden. Damit sparen Besucherinnen und Besucher bis zu 20 Prozent auf den regulären Eintrittspreis.
Bilder ©brinkertlück creatives
Weitere Infos unter: aargautourismus.ch/ baederkanton-aargau





HerzKreislaufErkrankungen (HKLErkrankungen) zählen in der Schweiz zu den bedeutendsten Gesundheitsproblemen und sind nach wie vor die häufigsten Volkskrankheiten. Trotz grosser Fortschritte in Medizin und Prävention bleiben sie die Hauptursache für Krankheit und Tod. Jährlich sterben in der Schweiz mehrere tausend Menschen an Herzinfarkt, Schlaganfall und anderen kardiovaskulären Leiden – das macht deutlich, wie wichtig es ist, diese Erkrankungen besser zu verstehen und ihnen wirksam vorzubeugen.
Was sind HKL-Erkrankungen?
Herz-Kreislauf-Erkrankungen umfassen eine Vielzahl von Krankheiten, die das Herz und die Blutgefässe betreffen. Dazu zählen unter anderem:
– Koronare Herzkrankheit (KHK): Verengung oder Verschluss der Herzkranzgefässe, die den Herzmuskel mit Sauerstoff versorgen. Sie kann zu Angina pectoris (Brustschmerzen) und Herzinfarkt führen.
– Herzinfarkt: Plötzlicher Verschluss eines Herzkranzgefässes, der zu einer Schädigung oder Absterben von Herzmuskelgewebe führt.
– Schlaganfall (Apoplex): Plötzliche Durchblutungsstörung im Gehirn durch Verschluss oder Platzen eines Gefässes, mit oft schweren neurologischen Folgen.
– Herzinsuffizienz: Unfähigkeit des Herzens, genügend Blut zu pumpen, um den Körper mit Sauerstoff zu versorgen.
– Bluthochdruck (Hypertonie): Erhöhter Druck in den Blutgefässen, der das Risiko für weitere Herz-Kreislauf-Erkrankungen deutlich erhöht.
– Periphere arterielle Verschlusskrankheit (pAVK): Verengung der Gefässe in Armen oder Beinen mit Durchblutungsstörungen.
Diese Erkrankungen können einzeln oder in Kombination auftreten und sind meist miteinander verbunden.
Warum sind HKL-Erkrankungen so häufig?
Die Ursachen für HerzKreislaufErkrankungen sind vielfältig und häufig eng mit dem Lebensstil und Umweltfaktoren verknüpft. Die wichtigsten Faktoren sind:
– Ungesunde Ernährung: Zu viel Fett, Zucker und Salz erhöhen das Risiko von Übergewicht, Bluthochdruck und hohem Cholesterinspiegel.
–
–

Herz-Kreislauf-Erkrankungen sind die häufigste Todesursache – sie verursachen etwa 30 bis 35 Prozent aller Todesfälle.
Bewegungsmangel: Regelmässige körperliche Aktivität stärkt das HerzKreislaufSystem und hilft, das Gewicht zu kontrollieren.
Rauchen: Tabakkonsum schädigt die Blutgefässe und fördert die Entstehung von Arteriosklerose (Gefässverkalkung).
– Übergewicht und Fettleibigkeit: Belasten Herz und Gefässe und erhöhen das Risiko für Diabetes und Bluthochdruck.
– Stress: Chronischer Stress kann den Blutdruck erhöhen und zu ungesundem Verhalten führen.
– Genetische Veranlagung: Eine familiäre Vorbelastung kann die Anfälligkeit erhöhen.
– Alter: Mit zunehmendem Alter steigt das Risiko für HerzKreislaufErkrankungen.
Studien belegen: Ein grosser Teil der Schweizer Bevölkerung lebt mit mindestens einem dieser Risikofaktoren, häufig sogar mehrere gleichzeitig. Besonders auffällig ist, dass die Prävalenz von Übergewicht und Bluthochdruck in den letzten Jahrzehnten zugenommen hat, was die Zahl der Betroffenen erhöht.

Demenz verstehen, bevor sie entsteht Demenz zählt zu den grössten gesundheitlichen Herausforderungen unserer Zeit. Immer mehr Menschen sind betroffen – mit gravierenden Folgen für Betroffene, Angehörige und Gesellschaft. Doch die Entstehung ist komplex. Prozesse im Gehirn, die bis heute nicht vollständig erforscht sind, führen langsam, oft über Jahre, zum Abbau geistiger Fähigkeiten. Wenn erste Symptome sichtbar werden, ist es meist schon sehr spät. Genau hier setzt Demenz Forschung Schweiz an: Unser Ziel ist es, die Ursachen frühzeitig zu erkennen – damit Demenz eines Tages verhindert oder wirksam verzögert werden kann.
Unsere Antwort: unabhängige Spitzenforschung
Damit dies gelingt, fördert Demenz Forschung Schweiz innovative Projekte in der gesamten Schweiz – unabhängig, interdisziplinär und mit internationaler Begleitung. Ein Scientific Board prüft alle Gesuche streng nach sdasdsadadsdasda
– Nicht rauchen: Das Aufgeben des Rauchens ist die effektivste Massnahme zur Verringerung der Herzinfarktsrisikos.
Die Zahlen hinter der Krankheit
Das Bundesamt für Statistik (BFS) veröffentlicht regelmässig Daten zu Todesursachen und Krankheitsprävalenz in der Schweiz. Diese zeigen klar: HerzKreislaufErkrankungen sind die häufigste Todesursache – sie verursachen etwa 30 bis 35 Prozent aller Todesfälle. Jährlich sterben rund 9000 bis 10 000 Menschen an den Folgen eines Herzinfarkts oder Schlaganfalls.
Neben der Sterblichkeit verursachen diese Krankheiten auch eine grosse Anzahl von Krankenhauseinweisungen und Arbeitsausfällen, was erhebliche soziale und wirtschaftliche Folgen mit sich bringt.
Der Schlüssel zur Reduktion der Erkrankungen
Das Gute an HKLErkrankungen ist, dass sie in vielen Fällen durch Prävention vermieden oder zumindest hinausgezögert werden können. Dabei spielt der Lebensstil eine entscheidende Rolle.
– Gesunde Ernährung: die reich an Obst, Gemüse, Vollkornprodukten, fettarmen Milchprodukten, gesunden Fetten (beispielsweise aus Fisch und Nüssen) und arm an gesättigten Fettsäuren, Zucker und Salz ist, schützt das Herz.
– Regelmässige Bewegung: Mindestens 150 Minuten moderate körperliche Aktivität pro Woche helfen, Blutdruck und Gewicht zu kontrollieren und das Herz zu stärken.
– Stressmanagement: Entspannungstechniken wie Meditation, Yoga oder Atemübungen können helfen, Stress zu reduzieren.
– Vorsorgeuntersuchungen: Blutdruck, Blutzucker und Cholesterin sollten kontrolliert werden, um frühzeitig Gegenmassnahmen einleiten zu können.
Viele kantonale Gesundheitsprogramme und auch Krankenkassen bieten heute Kurse und Beratung zur Prävention von HerzKreislaufErkrankungen an. Darüber hinaus informiert das Bundesamt für Gesundheit (BAG) mit Kampagnen über die Bedeutung eines gesunden Lebensstils.
Fortschritte in der medizinischen Behandlung Neben der Prävention sind die Fortschritte in der medizinischen Versorgung entscheidend, um die Auswirkungen von HerzKreislaufErkrankungen zu minimieren. Die moderne Medizin bietet heute eine breite Palette an Therapien:
– Medikamente: Blutdrucksenker, Cholesterinsenker (Statine), Blutverdünner und andere Medikamente können das Risiko von Komplikationen senken.
– Interventionelle Verfahren: Kathetergestützte Eingriffe wie Ballondilatation und Stentimplantation öffnen verengte Gefässe.
– Herzchirurgie: BypassOperationen oder Herzklappenersatz können bei schweren Erkrankungen Leben retten.
– Rehabilitation: Nach einem Herzinfarkt oder Schlaganfall sind spezialisierte Rehabilitationsprogramme wichtig, um die Genesung zu fördern.
Dank dieser Therapien ist die Sterblichkeit bei HerzKreislaufErkrankungen in den letzten Jahrzehnten deutlich zurückgegangen und viele Betroffene können trotz Diagnose ein aktives und erfülltes Leben führen. Jede und jeder Einzelne ist gefordert, die eigene Herzgesundheit durch bewusste Lebensstilentscheidungen zu fördern. Gemeinsam mit Unterstützung durch Gesundheitsinstitutionen kann so die Belastung durch HerzKreislaufErkrankungen in der Schweiz langfristig gesenkt werden.
Text Aaliyah Daidi
wissenschaftlicher Qualität. Nur die besten Projekte erhalten Unterstützung.
Jährlich werden bis zu zwölf Forschungsprojekte gefördert, mit maximal 300’000 Franken pro Projekt –von Fachhochschulen bis zu renommierten Universitäten. Ein Hauptfokus liegt auf der Erforschung jener Prozesse im Gehirn, die Demenz auslösen. Je besser wir diese Mechanismen verstehen, desto grösser die Chance auf wirksame Therapien und vorbeugende Massnahmen.



Wirkungsvolle Forschung dank Spenden Die staatliche Forschungsförderung ist wichtig, reicht im Bereich der Demenz aber nicht aus. Demenz Forschung Schweiz – Stiftung Synapsis füllt seit über 20 Jahren diese Lücke mit Geldern aus Privatspenden und Beiträgen von Organisationen – stets unabhängig und dem Ziel verpflichtet, die Demenzforschung in der Schweiz nachhaltig voranzubringen.
Danke für Ihre Spende!
IBAN: CH31 0900 0000 8567 8574 7
Twint-Spende mit QR-Code www.demenz-forschung.ch

«90 Prozent der Schlafstörungen sind stress- und umweltbedingt –und damit lösbar»
Erholsamer Schlaf ist essenziell für Gesundheit und Wohlbefinden. Dennoch fällt es vielen Menschen schwer, in der Nacht zur Ruhe zu kommen. Gesundheitliche Probleme sind häufige Folgen. Doch warum schlafen viele Menschen schlecht – und wie können ein optimales Schlafsystem sowie professionelle Schlafcoachings dabei helfen, dies zu beheben?


Herr Amann-Jennson, meine Smartwatch zeigt mir für die letzten zwei Wochen eine durchschnittliche Schlafdauer von sechs Stunden pro Nacht an. Ist das ausreichend? Schlaftracker sind zwar praktisch, weichen aber im Vergleich zum Goldstandard – dem Schlaflabor – oft um 30 Prozent oder mehr ab. Dennoch liefern sie hilfreiche Daten, etwa um Nächte miteinander zu vergleichen und Schlafstörer zu erkennen. Die optimale Schlafdauer variiert leicht, generell werden siebeneinhalb Stunden empfohlen. Wer dauerhaft nur sechs Stunden schläft, liegt unter dem gesunden Minimum. Warum gelten gerade siebeneinhalb Stunden als optimal?
Schlaf verläuft in Zyklen von etwa eineinhalb Stunden – vom Einschlafen bis zur Tief und REMSchlafphase. Fünf solcher Zyklen ergeben siebeneinhalb Stunden. Studien zeigen, dass Menschen, die diese Dauer erreichen, von einer besseren Lebensqualität und längeren Lebenserwartung profitieren.
Und wie steht es um die Schlafqualität der Schweizerinnen und Schweizer? Aktuelle Daten fehlen, doch eine ältere deutsche Studie zeigte, dass über 80 Prozent der Erwerbstätigen zu kurz oder schlecht schlafen. Manche Annahmen, wonach nur 30 Prozent betroffen seien, halte ich für zu optimistisch. Die internationale Studie «The Global Burden of Disease» belegt, dass nur fünf Prozent der Menschen kerngesund sind. Gesunde Menschen schlafen deutlich besser als Kranke. Daraus lässt sich ableiten, dass 95 Prozent biologisch nicht optimal schlafen – mit Folgen wie HerzKreislaufProblemen, Bluthochdruck, Diabetes und Depressionen. Ich habe mich deshalb in meiner 40jährigen schlafwissenschaftlichen Tätigkeit intensiv damit beschäftigt, wie sich Schlaf nachhaltig und messbar verbessern lässt.
Was ist das Ergebnis dieser Arbeit? Schlaf ist die wichtigste Ressource für unsere Gesundheit. Das SaminaSchlafsystem trägt diesem Umstand umfassend Rechnung. Wir bieten Schlafmessungen und Beratungen an – in der Schweiz unter anderem in Zürich, Basel und Luzern. Zudem bauen wir ein Netzwerk zertifizierter Schlafcoaches in der Schweiz auf.
Ein besonderes Highlight war, dass die Schweizer FussballNationalmannschaft zufällig beim Trainingsstart im Gesundheitszentrum Luisenhöhe (Horben, D) auf unser Konzept aufmerksam wurde – und alle Spieler samt Staff während dieser Zeit auf Samina geschlafen haben. Dort
95 Prozent schlafen biologisch nicht optimal – mit Folgen wie HerzKreislauf-Problemen, Bluthochdruck, Diabetes und Depressionen.
– Prof. Dr. med. h.c. Günther W. Amann-Jennson, Schlafpionier und Gründer
zum «Zertifizierten SchlafGesundCoach nach Prof. AmannJennson» startet Anfang November in Vorarlberg – eine einzigartige Möglichkeit, Teil unseres Netzwerks zu werden und anderen Menschen zu besserem Schlaf zu verhelfen. Wir richten uns nicht nur an Interessierte ohne Vorkenntnisse, sondern auch an Ärzte, Therapeuten und andere Fachkräfte, die Schlaf als entscheidenden Faktor in ihre Arbeit integrieren möchten. Meine Vision ist es, in jeder grösseren Stadt einen Ansprechpartner vor Ort zu haben, der Menschen mit Expertise und den passenden Produkten hilft, nachhaltig besser zu schlafen. Weitere Informationen und die Möglichkeit, direkt aktiv zu werden, unter: samina.ch
Der Weg zu besserem Schlaf
konnten sie die positiven Effekte auf Regeneration und Leistungsfähigkeit unmittelbar erleben.
Wo sehen Sie den grössten Hebel, um die Schlafqualität zu verbessern?
Im Schlafcoaching steht die Optimierung des Schlafplatzes im Vordergrund. Denn viele Schlafplätze versetzen den Körper in ständige Alarmbereitschaft. Lichtquellen, elektromagnetische Strahlung oder Schadstoffe verhindern den nächtlichen Regenerationsmodus. Ein gravierendes Problem ist die Schlafapnoe, die fast die Hälfte der Männer über 50 betrifft. Hier kommt es zu gefährlichen Atemaussetzern. Die übliche Therapie mit Atemmaske ist wirksam, aber unangenehm.
Vor über 15 Jahren habe ich gemeinsam mit Prof. Dr. Karl Hecht von der Charité Berlin das Konzept des Schrägschlafs entwickelt. Diese sanfte Methode hat sich besonders bei Schlafapnoe bewährt und verbessert die Lebensqualität vieler Betroffener. Was zeichnet das SaminaSchlafcoaching aus?
Ein wichtiger Bestandteil ist die Schlafanalyse, die bequem zu Hause durchgeführt wird. Mit einem wissenschaftlich validierten Messgerät, das am Handgelenk getragen wird und über einen Fingersensor verfügt, schaffen wir quasi ein MiniaturSchlaflabor für zu Hause. Gemessen werden unter anderem REMund Tiefschlafphasen, Atemaussetzer, Herzfrequenz, Schlafzyklen und Sauerstoffsättigung. Ich werte diese Daten aus und gebe massgeschneiderte Handlungsempfehlungen. Rund 90 Prozent aller Schlafstörungen sind stress und umweltbedingt – und damit lösbar.
Wie optimieren Sie den Schlafplatz konkret?
Mit unserem SaminaSchlafsystem, das wir seit 1989 kontinuierlich weiterentwickeln, schaffen wir ideale Voraussetzungen für bioenergetischen Schlaf. Dazu gehören vier Aspekte: orthopädisch korrekte Lagerung, nächtliche KörperErdung, GanzkörperSchrägschlaf sowie optimale Thermoregulation durch naturbelassene BioSchafschurwolle. Unsere Betten sind leicht geneigt, was die natürlichen Entgiftungsprozesse des Gehirns sowie das Lymphsystem unterstützt. Gleichzeitig kommt es zu einer deutlichen Entlastung des HerzKreislaufSystems, insbesondere im venösen Bereich.
Zudem ermöglicht unser Medizinprodukt Lokosana eine nächtliche KörperErdung, die das parasympathische Nervensystem aktiviert. Das sorgt für spürbaren Stressabbau und optimale Regeneration. Menschen verbringen im Schnitt 120 Tage pro Jahr schlafend, doch nur wenige investieren bewusst in diese Lebenszeit. Hier möchten wir ein Umdenken anstossen.
Sie haben erwähnt, dass Sie seit 1989 am Schlafsystem arbeiten. Wie sahen die Anfänge aus?
Die Initialzündung war meine 13jährige Arbeit als Schlafpsychologe in Feldkirch. Ich stellte fest, dass psychische Probleme fast immer mit schlechtem Schlaf einhergingen. Deshalb beschloss ich, den Schlaf gezielt zu verbessern. Ich entwickelte ein ganzheitliches «SchlafGesundKonzept» und baute den ersten Prototyp unseres Systems. Die Revolution war der doppelseitige, frei schwingende Lamellenrost als Herzstück des Bettes sowie ein Aufbau nach dem Vorbild des menschlichen Körpers – ausschliesslich aus Naturmaterialien.
Meine Frau Elisabeth investierte ihre Ersparnisse als Startkapital und leitete die erste eigene Näherei.
Sie halten auch regelmässig Vorträge über Schlaf. Können Sie uns ein aktuelles Beispiel nennen?
Anfang September war ich Referent beim BodenseeKongress für Molekular und Orthomolekulare Medizin in Ermatingen. Dort habe ich vor Fachpublikum die Bedeutung des Schlafs für Prävention und Therapie erläutert. Viele chronische Erkrankungen lassen sich nur dann erfolgreich behandeln, wenn auch der Schlaf verbessert wird. Diese Erkenntnis gewinnt in der modernen Medizin an Bedeutung.
Und wie sehen die nächsten Schritte für Samina aus?
Wir sind weltweit aktiv und erhalten regelmässig Rückmeldungen von Menschen, die dank unseres Systems wieder gesunden Schlaf finden konnten. In Fachkreisen werden wir sogar «als das gesündeste Bettsystem der Welt» bezeichnet. Aktuell arbeite ich am Aufbau eines Netzwerks zertifizierter Schlafcoaches, speziell in der Schweiz. Die nächste Ausbildung
In den Niederlassungen in Zürich, Basel und Luzern sowie zertifizierten Samina-Partnern kann man eine Schlafmessung buchen oder sich beraten lassen. Ein zusätzliches Angebot ist der Schlaf-Selbsttest auf Basis des Pittsburgh Sleep Quality Index (PSQI). Dieser wissenschaftlich anerkannte Fragebogen kann online heruntergeladen und ausgewertet werden. Der nächste Schritt könnte eine professionelle Schlafmessung sein.
samina.ch/psqi
Weitere spannende Informationen rund um gesunden Schlaf und Schlafpsychologie gibt es auch auf der persönlichen Website von Günther W. Amann-Jennson:
amann-jennson.com
Jetzt besser schlafen – wir beraten Sie persönlich! Auf unserer Website finden Sie Ihre Ansprechpartner:innen, die Sie kompetent beraten und auf dem Weg zu erholsamem, gesundem Schlaf begleiten.
samina.ch/kontakt

Dr.
«Wir
Das Sehen ist der wichtigste Sinn des Menschen. Dennoch scheuen viele den Weg in die Augenarztpraxis. Bei «Augenärzte Viadukt» in Zürich setzt man daher auf persönliche Beratung, erstklassige augenmedizinische Expertise – und ein Angebot, das auch operative Dienstleistungen umfasst.

med. Philipp Fischbacher
Augenarzt
Herr Fischbacher, Sie haben kürzlich die Augenarztpraxis «Augenärzte Viadukt» in Zürich eröffnet. Wie würden Sie diese in Ihren eigenen Worten beschreiben? Wir haben uns bewusst für einen Standort im pulsierenden Herzen der Stadt entschieden, direkt an der Grenze zwischen den Kreisen 4 und 5. Hier möchten auch wir ein integraler Bestandteil des städtischen Lebens sein. Aus diesem Grund besteht unser Team aus Ärztinnen und Ärzten, die in der Stadt verwurzelt und mit ihr verbunden sind. Es erfüllt uns mit Freude, den Menschen hier ein umfassendes augenmedizinisches Dienstleistungsportfolio anzubieten.
Sie haben bereits die Praxis «Augenärzte Zug» erfolgreich aufgebaut und geleitet. Was hat Sie dazu bewogen, in die Limmatstadt zu expandieren?
Es boten sich uns gleich zwei grossartige Gelegenheiten, die wir schlicht und einfach ergreifen mussten: Einerseits ergab sich die attraktive Möglichkeit, an diesem hervorragenden Standort eine bestehende Praxis inklusive OPRäumlichkeiten zu übernehmen. Andererseits sind wir ein gut funktionierendes Kollektiv mit einer engen Bindung zu Zürich (entweder wohnhaft in Zürich oder Ausbildung am Universitätsspital Zürich). Wir möchten unsere Dienstleistung, die wir bereits im Kanton Zug anbieten, auch Zürcher Patientinnen und Patienten zugänglich machen.
PUBLIREPORTAGE
Denn im Idealfall ist die Augenmedizin eine Partnerschaft, die man von Kindesbeinen an bis ins hohe Alter pflegt. Vertrauen spielt dabei eine entscheidende Rolle.
– Dr. med. Philipp Fischbacher
man Krankheiten vorbeugen, die, wenn sie unentdeckt bleiben, später zu erheblichen Einschränkungen führen können.
Dies beinhaltet die augenärztliche Sprechstunde, orthoptische Spezialsprechstunde (Sehschule) und operative Tätigkeiten in einem hochmodern ausgerüsteten Operationssaal. Zusätzlich ergab sich dadurch die Möglichkeit für meine Frau Dr. med. Sandra FischbacherFurrer, nach sechs Jahren Familienpause den beruflichen Wiedereinstieg vorzunehmen. Viele Menschen zögern noch immer, eine Augenärztin oder einen Augenarzt aufzusuchen. Bei Sehschwierigkeiten konsultieren sie oft zunächst eine:n Optiker:in. Woran liegt das Ihrer Meinung nach?
Ich nehme generell einen gewissen Respekt vor dem Besuch bei einer Augenärztin oder einem Augenarzt wahr. Über die genauen Gründe möchte ich nicht spekulieren. Viel wichtiger ist mir, zu betonen, dass man sich einfach trauen sollte, bei uns vorbeizukommen. Denn im Idealfall ist die Augenmedizin eine Partnerschaft, die man von Kindesbeinen an bis ins hohe Alter pflegt. Vertrauen spielt dabei eine entscheidende Rolle.
Bringen Sie Ihre Durchblutung jetzt in Schwung. Gerade in der kühlen Jahreszeit ist ein gut funktionierender Blutkreislauf der Schlüssel zu Energie und Wohlbefinden.
Wann sollte man sich unverzüglich zur Augenärztin oder zum Augenarzt aufmachen?
Auf jeden Fall dann, wenn sich die Sehkraft merklich verändert. Insbesondere, wenn man Flecken wahrnimmt oder sich optische Störungen zeigen, die an Spinnweben erinnern. Und wenn einem ab dem 40. Lebensjahr aufgrund der altersbedingten Kurzsichtigkeit das Lesen schwerfällt und die Arme langsam zu kurz werden, um ein Buch ausreichend von sich wegzuhalten, sollte man die Gelegenheit für eine umfassende Augenuntersuchung nutzen. Ebenfalls ist eine vorsorgliche Augenuntersuchung zu empfehlen, wenn in der Familie Augenkrankheiten bekannt sind. Zudem ist mir als Vater von zwei Kindern wichtig, dass Kinder in ihrer Sehentwicklung fachmännisch begleitet werden. Gerade die zunehmende Myopie (Kurzsichtigkeit) ist ein Thema, das die Eltern beschäftigt.
Zudem ergibt eine Konsultation auch dann Sinn, wenn man keine Symptome verspürt. Denn mit proaktiven Augenchecks kann
Können Sie ein Beispiel dafür nennen? Den Grünen Star, das sogenannte Glaukom, bemerkt man anfangs nicht. Darunter wird eine Gruppe von Augenkrankheiten verstanden, bei denen der Sehnerv unwiderruflich geschädigt wird. In den meisten Fällen ist ein erhöhter Augendruck die Ursache dafür. Unbehandelt kann dies zu Sehstörungen führen, die das Gesichtsfeld allmählich einschränken. Doch durch eine frühzeitige Entdeckung im Rahmen einer augenmedizinischen Routineuntersuchung lässt sich der Verlauf aufhalten. Daher empfehle ich, den Augendruck ab dem 40. Lebensjahr alle drei Jahre überprüfen zu lassen und ab dem 50. Lebensjahr sogar alle zwei bis drei Jahre. Unser Team ist sehr versiert und erfahren, wenn es um Augenkrankheiten geht – und mit PD Dr. med. Mayss AlSheikh haben wir eine NetzhautSpezialistin mit langjähriger Erfahrung in der Abklärung und Behandlung verschiedenster Augenerkrankungen an Bord. Ihr besonderer Schwerpunkt liegt im Bereich der Medical Retina. Dies ist ein weiterer Beleg für die hohe Spezialisierung, die wir in unserer Praxis anbieten. Weitere Informationen unter: augenaerzte-viadukt.ch


Warum eine gute Blutzirkulation so wichtig ist
Gerade in der kühlen Jahreszeit kann die Blutversorgung des Körpers ins Stocken geraten. Ein gut funktionierender Blutkreislauf ist entscheidend für Wohlbefinden und Energie. Unser Körper enthält etwa fünf Liter Blut, das mit rund vier Kilometern pro Stunde durch die Gefässe fliesst und jede Zelle mit lebenswichtigen Nährstoffen, Sauerstoff und Immunzellen versorgt. Fit durch den Herbst: Warum gesunde Durchblutung so wichtig ist
Wenn die Temperaturen sinken, ziehen sich die Blutgefässe zusammen, um die Wärme im Körperinneren zu halten. Das führt oft dazu, dass Hände und Füsse kalt werden oder unangenehme Symptome wie Kribbeln, eingeschlafene Gliedmassen oder Wadenkrämpfe auftreten. Diese Warnzeichen deuten auf eine gestörte Blutzirkulation hin und können auch durch Stress, Bewegungsmangel, Rauchen oder Krankheiten wie Diabetes begünstigt werden.
Viele Menschen wissen gar nicht, wie grundlegend eine gesunde Blutzirkulation für fast alle Prozesse im Körper ist: Sie spielt eine entscheidende Rolle für die Versorgung der Organe, das Immunsystem, die Wundheilung und selbst für die Entgiftung. Ist
die Durchblutung gestört, kann sich das in zahlreichen kleinen Beschwerden äussern, wie etwa häufig kalten Extremitäten oder mangelnder körperlicher Belastbarkeit.
Ganzheitliche Tipps für gesunde Gefässe Die beste Massnahme gegen Durchblutungsstörungen ist regelmässige
Bewegung an der frischen Luft. Der Herbst bietet dazu ideale Möglichkeiten:
Herbstwanderungen entspannen und fördern die Blutzirkulation.
Nordic Walking ist ein effektives Ganzkörpertraining.
• Velotouren zum Stärken der Ausdauer und des Kreislaufs.
Diese Aktivitäten bringen den Kreislauf in Schwung, machen Spass und stärken das Immunsystem für die kühlere Jahreszeit. Auch eine moderate, tägliche Bewegung bringt langfristig mehr als einmalige Anstrengungen am Wochenende.
Ernährung und weitere Faktoren
Ergänzen Sie Ihren Alltag mit weiteren Faktoren, die für die Gefässgesundheit entscheidend sind:
• Rauchverzicht zum Schutz der Gefässe.
• Gewichtskontrolle.
• Eine ausgewogene, fettarme Ernährung. Indem Sie Ihr Essen möglichst bunt zusammenstellen und hochwertige Fette wählen, liefern Sie dem Körper vielseitige Nährstoffe und stärken die Gefässgesundheit.
Für Ihre gesunde Blutzirkulation von morgen
Eine gesunde Blutversorgung ist mehr als Kreislaufsache: Sie ist der Fluss des Lebens und entscheidend für die Versorgung aller Zellen und Organe – für Wundheilung, Infektabwehr und Entgiftung.
Insbesondere im Herbst lohnt es sich, auf die eigenen Körperzeichen zu achten und die Gesundheit aktiv zu fördern. Denn ein intakter Blutkreislauf zahlt sich mit mehr Energie, Vitalität und Widerstandskraft aus – nicht nur jetzt, sondern das ganze Jahr hindurch.
Traditionelle Unterstützung aus Tibet Das tibetische Arzneimittel Padma 28N basiert auf jahrhundertealtem Wissen und enthält 19 verschiedene Kräuter sowie pflanzlichen Campher und Calciumsulfat. Es wird bei Durchblutungsstörungen eingesetzt, wenn Hände und Füsse einschlafen oder Wadenkrämpfe plagen.

Die Rezeptur von Padma 28N ist einzigartig: Sie vereint die Vorzüge bitter-herber, naturbelassener Kräuter mit wichtigen Mineralstoffen, die nach tibetischer Lehre gezielt das „bewegende Prinzip“ fördern. Dieses Prinzip steht in der traditionellen Medizinkunde für einen freien, aktiven Blutfluss im ganzen Organismus. Dies ist ein zugelassenes Arzneimittel. Lesen Sie die Packungsbeilage. PADMA AG padma.ch



Dr. med. univ. Livia
Zwar leiden nur 0,1 bis 0,3 Prozent der Bevölkerung an Clusterkopfschmerzen, Männer dreimal häufiger als Frauen, doch die Betroffenen erleben enorme Schmerzen. Aufgrund der Seltenheit wird die Erkrankung oft fälschlicherweise als Migräne oder Nebenhöhlenentzündung diagnostiziert. Das Leben der Betroffenen ist stark eingeschränkt.
Was sind Clusterkopfschmerzen?
Clusterkopfschmerzen sind extrem starke einseitige Kopfschmerzen, die in Attacken auftreten, episodisch oder chronisch. Dr. med. Livia Granata, Fachärztin für Neurologie und Schmerzmedizin im Schmerzzentrum Granata in Zürich, beschreibt: «Clusterkopfschmerz Attacken sind

die schlimmsten Schmerzen, die man sich vorstellen kann, vergleichbar mit Messerstichen ins Auge.» Typisch sind Attacken von einer bis drei Stunden, begleitet von Rötung, Tränenfluss und oft von einer verstopften Nase.
Zwischen den Attacken sind die Betroffenen meist beschwerdefrei, was Verständnis im sozialen Umfeld erschwert. Chronische Patient:innen können bis zu zehn Attacken pro Tag erleben.
Wer ist betroffen?
Überwiegend Männer sind betroffen, fast alle Patient:innen rauchen. Die Ursachen sind nicht vollständig bekannt, es gibt jedoch Hinweise auf genetische Faktoren.
Leidensdruck
Der Leidensdruck ist enorm: Patient:innen können kaum arbeiten oder schlafen aus Angst vor Attacken. Rund 64 Prozent der Betroffenen haben Suizidgedanken.
Medikamentöse Behandlung
Zur Akutbehandlung stehen verschiedene Medikamente zur Verfügung, die sofortige Wirkung ist jedoch oft nicht ausreichend, um den Schmerz vollständig zu lindern.
Publireportage
Wieso braucht es eine Vollprothese, wenn man mit einer Salbe schmerzfrei durchs Leben gehen kann?
Mit Soufrol® Arthro Crème beweglich ohne Schmerzen.
Andre aus dem Mittelland weiss, was eine Operation am Knie mit sich bringt und erzählt aus eigener und langjähriger Erfahrung.
«Schon seit Jahren leide ich unter teilweise starken Knie schmerzen. Leider ist die einzige Lösung, eine Vollprothese einzusetzen. Da ich bei meinem anderen Knie diese Operation durchgeführt habe und weiss, was es alles mit sich bringt, möchte ich dies so lange wie möglich hinaus zögern. Daher kam Soufrol® Arthro Crème mehr als passend in mein Leben. Durch die Dauerentzündung habe ich mehrmals die Woche starke Schmerzen und habe diesbezüglich schon viel an Crèms ausprobiert», sagt Andre.
Soufrol® hat sein Leben verbessert, schon bei der ersten Anwendung. Deshalb gibt er eine ehrliche Weiterempfehlung der Crème ab.
«Ich kann die Soufrol® Arthro Crème mit keiner anderen vergleichen und das will ich auch nicht. Schon seit der ersten Anwendung im Januar merkte ich eine sofortige Wirkung. Es fühlt sich angenehm kühlend und leicht auf meiner Haut an. Ich kann schmerzfreier durch das Leben gehen und auch wieder gewisse körperliche Betätigungen erleben wie z.B. wandern. Mein Knieschmerz zog sich bis in die Wade, was wiederum Muskelkrämpfe auslöste. Daher ist Soufrol® Muscle Crème die perfekte Ergänzung.»
«Ich kann ganz ehrlich sagen, dass Soufrol® mein Leben ver bessert hat und ich es immer wieder weiterempfehlen würde.»
Gebro Pharma AG, CH-4410 Liestal, Tel.: +41 61 926 88 33, Fax: +41 61 926 88 44, www.gebro.ch
Beim Kauf einer Soufrol® Arthro Crème 60 g erhalten Sie CHF 2.– Rabatt in Ihrer Apotheke oder Drogerie
Gültig bis 30.09.2025, nicht kumulierbar

Patient:innen können kaum arbeiten oder schlafen aus Angst vor Attacken.
Therapie im Schmerzzentrum Granata Patient:innen, die auf Standardtherapien nicht ansprechen, erhalten prophylaktische spezialisierte Schmerzbehandlungen, die auf neuestem wissenschaftlichem Stand basieren. Das Schmerzzentrum Granata nutzt multimodale Therapieansätze, einschliesslich individuell abgestimmter medikamentöser Behandlungen, um die Attacken zu stoppen bzw. die und Schmerzintensität deutlich zu reduzieren.
Erfolge und Ausblick
Studien zeigen, dass spezialisierte Therapieprotokolle bei therapieresistenten Patienten deutlich wirksam sein können. Die Lebensqualität Betroffener kann signifikant verbessert werden, und die Forschung arbeitet daran, Behandlungsmöglichkeiten kontinuierlich zu erweitern.
Schmerzzentrum Granata
Das 2017 gegründete Schmerzzentrum Granata in Zürich bietet umfassende Expertise in neurologischer Schmerzmedizin und multimodalen Therapieansätzen. Das Team um Dr. med. Livia Granata, Neurologin und Schmerzspezialistin, Dr. med. Leander Sakellaris, Anaestesist und Schmerzspezialist und Dipl.Ärztin und Neurologin Bettina Anders behandelt chronische Schmerzen wie Kopf, Nacken und Rückenbeschwerden sowie damit verbundene psychische Begleiterkrankungen.
Weitere Informationen unter: schmerzzentrum-granata.com

✓ Kühlende Schmerzlinderung
✓ Förderung der Gelenkbeweglichkeit
✓ Wirksam bei Entzündungen und Schwellungen in den Gelenken



Gesundheit ist mehr als die Abwesenheit von Krankheit. Sie ist ein Gefühl von Lebendigkeit, Balance und innerer Stärke. Wer sich mit holistischer – also ganzheitlicher – Gesundheit beschäftigt, merkt schnell: Es geht nicht nur um körperliche Fitness oder gesunde Ernährung, sondern um das grosse Ganze. Körper, Geist, Seele und Umwelt sind untrennbar miteinander verbunden. Wenn eines aus dem Gleichgewicht gerät, hat das Auswirkungen auf alle anderen Bereiche. Alles hängt zusammen
Stellen wir uns einen Menschen vor, der dauerhaft unter Druck steht. Die Gedanken kreisen, der Schlaf bleibt aus und schon nach kurzer Zeit reagiert auch der Körper: Verspannungen, Verdauungsprobleme, Infektanfälligkeit. Umgekehrt können körperliche Beschwerden das seelische Wohlbefinden trüben. Holistische Gesundheit bedeutet, diese Wechselwirkungen nicht zu übersehen, sondern bewusst einzubeziehen. Sie fragt nicht nur «Was tut weh?» , sondern auch «Warum ist es aus dem Gleichgewicht geraten?»
Ernährung als Fundament Ernährung spielt eine zentrale Rolle. Was wir zu uns nehmen, liefert nicht nur Energie, sondern beeinflusst Hormone, Stimmung und sogar Konzentrationsfähigkeit. Holistische Ansätze setzen auf frische, natürliche Lebensmittel, die den Körper nähren und die Selbstheilungskräfte ankurbeln. Aber es geht nicht nur darum, was wir essen, sondern auch wie: Achtsames Essen – bewusstes Schmecken,
Wer Körper, Geist, Seele, Beziehungen und Umwelt als Einheit begreift, entdeckt Gesundheit nicht als Endziel, sondern als Prozess.
Kauen, Geniessen – wirkt wie ein kleines Ritual, das Körper und Geist gleichermassen zur Ruhe bringt.
Bewegung macht glücklich Ähnlich verhält es sich mit Bewegung. Sie ist weit mehr als ein Mittel, um Muskeln zu formen oder Kalorien zu verbrennen. Bewegung kann Stress abbauen, Glückshormone freisetzen und uns das Gefühl geben, mit uns selbst im Einklang zu sein. Ob Yoga, Spaziergänge im Wald oder Tanzen im Wohnzimmer – entscheidend ist nicht die Intensität, sondern die Freude daran. Holistische Gesundheit lädt dazu ein, Bewegung als selbstverständlichen Teil des Lebens zu sehen, nicht als Pflichtprogramm.
Der Wert innerer Ruhe
Ebenso wichtig ist die mentale Ebene. Stress, Sorgen und innere Unruhe wirken wie unsichtbare Störfelder. Meditation, Atemtechniken oder

F ÜHRENDINDER HAFERFORSCHUNG
Beruhigt und schützt trockene, empfindliche und sogar zu Ekzemen neigende Haut.


Journaling helfen, Gedanken zu sortieren und den Blick nach innen zu richten. Wer sich regelmässig kleine Inseln der Ruhe schafft, gewinnt nicht nur Gelassenheit, sondern stärkt auch seine Widerstandskraft gegenüber den Herausforderungen des Alltags. Schlaf spielt dabei eine entscheidende Rolle: Er ist das vielleicht wichtigste Regenerationsprogramm, das uns zur Verfügung steht.
Gesundheit im sozialen und ökologischen Kontext Ganzheitliche Gesundheit denkt über das Individuum hinaus. Menschen sind soziale Wesen – wir brauchen Gemeinschaft, Austausch und Nähe. Studien zeigen, dass stabile Beziehungen und soziale Bindungen entscheidend für ein langes, erfülltes Leben sind. Gleichzeitig sind wir Teil einer Umwelt, die direkt auf unsere Gesundheit wirkt: saubere Luft, Lärmpegel, Zugang zu Natur. Wer sich für
Nachhaltigkeit engagiert, schützt damit nicht nur den Planeten, sondern auch die eigene Lebensqualität. Ein neues Verständnis von Gesundheit Immer mehr Menschen, Unternehmen und auch Ärztinnen und Ärzte erkennen, dass Gesundheit nicht in Schubladen gedacht werden kann. Klassische Medizin und alternative Ansätze müssen sich nicht gegenseitig ausschliessen, sondern können einander ergänzen. Während die Schulmedizin akute Probleme gezielt behandelt, sorgt der holistische Blick dafür, langfristig vorzubeugen und den Menschen in seiner ganzen Lebensrealität zu sehen.
Kleine Schritte, grosse Wirkung
Holistische Gesundheit ist keine Dogmatik und keine starre Lehre. Sie lebt von kleinen, bewussten Entscheidungen im Alltag: öfter zu Fuss gehen, ein Glas Wasser mehr trinken, das Handy rechtzeitig weglegen und sich Zeit für Gespräche mit Freund:innen nehmen. In der Summe können diese Schritte eine enorme Wirkung entfalten.
Balance als Lebenskunst Holistische Gesundheit ist letztlich eine Einladung, das Leben in Balance zu bringen – in all seinen Facetten. Es geht nicht darum, perfekt zu sein, sondern darum, bewusster mit sich selbst umzugehen. Wer Körper, Geist, Seele, Beziehungen und Umwelt als Einheit begreift, entdeckt Gesundheit nicht als Endziel, sondern als Prozess. Ein Prozess, der nicht nur vitaler macht, sondern auch klarer, ruhiger und zufriedener.
Text Aaliyah Daidi
Babyhautpflege ab dem 1. Lebenstag
✓ Mit dem einzigartigen 3-fachen Haferkomplex*
✓ Dermatologisch und pädiatrisch getestet


Dr. Farkas GmbH • Brandreport 9
«Wir
Pestizide und Schwermetalle im Essen, Mikroplastik und PFAS im Wasser, Feinstaub in der Luft, Medikamentenrückstände und Dauerstress – unser Körper wird zur Sammelstelle moderner Schadstoffe. Eine einzigartige Therapie verspricht nachhaltige Verbesserung von Folgebeschwerden wie Erschöpfung, Müdigkeit und vorzeitigem Altern: die Blutreinigung.

Ein grosser Teil der Schadstoffe, denen wir tagtäglich ausgesetzt sind, gelangt ins Blut und wird in Organen und Geweben eingelagert. Der Körper kann viele dieser Substanzen nur unzureichend oder gar nicht abbauen. Sie stören Zellprozesse, fördern stille Entzündungen und beeinträchtigen die Regeneration. Diese Belastung bleibt anfangs unbemerkt, ist aber Risikofaktor für Erschöpfung, Autoimmunprozesse und frühzeitiges Altern. Ein Reset für den Organismus verspricht die Blutreinigung von Dr. Farkas GmbH in Gachnang. Frau Dr. Farkas, weshalb haben Sie sich entschieden, die HemoPure-Blutreinigung in der Schweiz anzubieten?
Die Entscheidung, HemoPure in die Schweiz zu bringen, hatte auch einen sehr persönlichen Grund. Nach einer schweren Corona Infektion entwickelte ich massive Hautprobleme und Erschöpfung. Nichts half – bis ich eine Vollblutreinigung wagte. Innerhalb von fünf Tagen verschwanden die Symptome vollständig und sind bis heute nicht zurückgekehrt. Diese Erfahrung war ein Wendepunkt und der Grund, warum ich HemoPure nach Gachnang geholt habe.
Was ist an Ihrem Verfahren so einzigartig?
HemoPure kombiniert drei Technologien. Erstens: Eine AdsorberTechnologie mit riesiger Oberfläche filtert gezielt Schadstoffe aus dem Blut. Zweitens: Eine milde Hyperthermie erwärmt das Blut, verbessert die Durchblutung und aktiviert das Immunsystem. Drittens: Das Blut wird mit Sauerstoff angereichert, was die Zellregeneration unterstützt und aktiv latente Infektionen bekämpft. In einer einzigen Sitzung wird das gesamte Blutvolumen circa zehnmal gereinigt – bis zu 65 Liter in nur drei Stunden. Die Kombination, die individuelle Anpassung und die Tatsache, dass wir Vollblut statt nur Plasma reinigen, machen das Verfahren einzigartig.
Erkennt man in einem normalen Blutbild toxische Belastungen?
Leider nein. StandardLabortests zeigen vor allem akute Entzündungen oder Organschäden. Viele Umweltgifte und stille Entzündungen bleiben jedoch unsichtbar. Erst Spezialanalysen können Belastungen durch Schwermetalle, Pestizide oder Mikroplastik nachweisen. HemoPure setzt genau hier an: Wir wollen nicht nur Symptome behandeln, sondern Ursachen beseitigen.
Wie läuft eine Blutreinigung ab?
HemoPure ist ein dreitägiges Gesundheitsprogramm mit Vorbereitung, Durchführung und Nachsorge. Am ersten Tag prüfen wir Laborwerte, führen ein ausführliches Gespräch und beginnen mit Infusionen, die Leber und Nieren entlasten. Zudem mobilisieren wir mit Tiefenultraschall, Wärme und elektrischen Impulsen Schadstoffe aus dem Gewebe. Der zweite Tag steht im Zeichen der eigentlichen Blutreinigung. Das Blut durchläuft in zweieinhalb bis drei Stunden
unsere drei Module – Adsorption, Hyperthermie und Sauerstoffanreicherung. Direkt im Anschluss an die Blutreinigung erhält der Körper aufbauende Infusionen mit Vitaminen, Mineralstoffen und Aminosäuren. Am dritten Tag erfolgt die Nachsorge: Kontrolle des KatheterEinstichkanals, Beratung zu Mikronährstoffen und Empfehlungen für einen nachhaltigen Neustart. An allen drei Tagen werden unsere Klientinnen und Klienten individuell begleitet – medizinisch und kulinarisch mit frisch zubereitetem BioMenü.
Wie lange hält der Effekt an?
Wir sprechen weniger von einem kurzfristigen Effekt, sondern von einem kontinuierlichen Regenerationsprozess. Die volle Wirkung entfaltet sich in den zwei bis drei Monaten nach der Behandlung, wenn sich Stoffwechsel, Immunsystem und Zellprozesse stabilisieren. Bei chronisch Erkrankten kann es anfangs zu einer kurzen Erstverschlechterung kommen, bevor es dann deutlich bergauf geht. Viele berichten, dass belastende Symptome nach einigen Wochen verschwunden sind oder sich spürbar reduziert haben.
Wie oft ist eine Blutreinigung notwendig?
Bei chronischen Erkrankungen starten wir meist mit einer einmaligen HemoPureBehandlung und begleiten danach individuell weiter. Viele nutzen unser Nachbetreuungsprogramm mit Darmsanierung, Mitochondrienaufbau oder Mikronährstofftherapie.
Je nach Situation kann eine Wiederholung nach 6 bis 18 Monaten sinnvoll sein, oft in kompakterer Form.
Welche Erfahrungen haben
Sie mit Long Covid?
Hier sehen wir besonders eindrückliche Veränderungen: mehr Energie, bessere Konzentration, deutlich
weniger Crashs bis hin zur völligen Symptomfreiheit. Für uns als Team ist es jedes Mal bewegend, mitzuerleben, wie Menschen nach unzähligen Therapieversuchen mit der HemoPureBlutreinigung ihr Leben endlich wieder zurückgewinnen. Ist HemoPure auch präventiv sinnvoll? Absolut, vor allem wenn man gesund alt werden und diese Zeit ohne Einschränkungen geniessen will. Eine Blutreinigung alle zwei bis drei Jahre kann den Körper entlasten und helfen, chronische Erkrankungen zu vermeiden.
Weitere Informationen unter: dr-farkas.ch und hemopure.ch
Alpstein Clinic AG • Brandreport

Warum Prävention der wahre Luxus ist – und wie die Alpstein Clinic Gais dabei neue Massstäbe setzt.
and aufs Herz: Wir gehen öfter mit dem Auto zum Service, als dass wir unseren eigenen Körper checken lassen. Dabei ist das Herz – und alles drum herum – deutlich schwerer zu ersetzen als eine Zündkerze.
Die gute Nachricht: Gesundheit ist gestaltbar! Studien zeigen, dass nur rund 20 Prozent unseres Wohlbefindens in den Genen stecken. Die übrigen 80 Prozent liegen in unseren Händen – sprich: in Lebensstil, Ernährung, Bewegung und kluger Vorsorge. Wer also meint, es läge alles am Schicksal, darf hier getrost umdenken.
Und genau da setzt die Alpstein Clinic Gais an. Ihr Premium Präventionsprogramm 3.0 ist nicht der nächste «Check up light», sondern ein ganzheitliches Konzept, das modernste Diagnostik mit erfahrener Ganzheitsmedizin verbindet. Von Herz Kreislauf über Stoffwechsel, Nervensystem und Darmflora bis hin zu Zähnen (ja, auch da können stille Störfelder lauern!) – alles wird in die Analyse miteinbezogen.
Das Spannende: Viele Krankheiten kündigen sich lange vorher an. Schon 15–20 Jahre bevor Herzinfarkt, Schlaganfall oder Demenz zuschlagen, lassen sich messbare Risikofaktoren erkennen. Laut einer grossen US Studie könnten so 60 Prozent aller Schlaganfälle und 40 Prozent der Demenzfälle verhindert werden. Wer rechtzeitig hinschaut, lebt länger – und vor allem besser.
Mehr als ein Check-up: das Baukastenprinzip
Das Programm ist klar strukturiert:
Basismodul: die ärztliche Exploration, eine ausführliche Anamnese, grundlegende Laborwerte, Herz Kreislauf Parameter sowie eine zahnmedizinische Untersuchung – Zusatzmodule: für alle, die genauer hinschauen wollen – etwa zu Genetik, Stoffwechsel, Toxinen, neurodegenerativen Erkrankungen oder hormonellen Faktoren. So entsteht ein massgeschneidertes Vorsorgeprogramm.
Diagnostik, die in die Tiefe geht
Die Alpstein Clinic nutzt eine aussergewöhnlich breite Palette modernster Verfahren, die weit über das hinausgeht, was man von klassischen Vorsorgeuntersuchungen kennt. Dazu zählen:
– Herz und Kreislauf: Belastungs EKG, VO2max Messung (maximale Sauerstoffaufnahme), Herzratenvariabilität, moderne Cardisiographie – ein innovatives, KI gestütztes Verfahren, das frühe Herzprobleme sichtbar macht, lange bevor Symptome auftreten
– Nervensystem: Analyse des vegetativen Nervensystems, Regulationsthermographie, Tests zur neuromuskulären Fitness
– Stoffwechsel und Energie: Körperzusammensetzung, biologisches Fitnessalter, Atemgasanalysen
zur Bestimmung von Fettverbrennung und mitochondrialer Leistungsfähigkeit
– Immunsystem: Laboranalysen zu chronischen Entzündungen, Autoimmunmarkern und Abwehrschwächen
– Darmgesundheit: Mikrobiomanalysen, die aufzeigen, wie Ernährung und Darmflora die Gesamtgesundheit beeinflussen – Entgiftung: Untersuchung von Leber und Nierenfunktion, Belastung durch Umweltgifte und Metalle, oxidative Stressmarker
– Genetik: Analyse von Risikoprofilen, Stoffwechselgenen und Entgiftungskapazitäten
– Zahnmedizin: Ganzheitliche Untersuchung von Zahnstatus, Kiefer und möglichen Störfeldern – denn unerkannte Infektionsherde im Mund können das Immunsystem und sogar den Herz Kreislauf erheblich belasten
Beispiel Cardisiographie: Herzgesundheit sichtbar machen Die Cardisiographie zeigt, wie Prävention heute funktioniert: nicht invasiv, schnell und hochpräzise. Ähnlich wie beim EKG werden elektrische Signale des Herzens gemessen – ergänzt durch eine KIgestützte Auswertung, die winzige Abweichungen erkennt. Schon frühe Anzeichen einer koronaren Herzkrankheit oder Durchblutungsstörungen werden sichtbar. Der Patient oder die Patientin sitzt entspannt, die Untersuchung dauert nur wenige Minuten und am Ende steht ein klarer Befund.
Das Ziel: gesunde Jahre gewinnen
Das Besondere an diesem Ansatz: Am Ende steht keine blosse Sammlung von Messwerten, sondern eine individuelle Risikoanalyse. Ärztinnen und Ärzte der Alpstein Clinic besprechen die Ergebnisse ausführlich und entwickeln gemeinsam mit den Patientinnen und Patienten konkrete Empfehlungen – von Ernährung und Bewegung über Schlafhygiene bis hin zum Stressmanagement.
So wird Prävention praktisch: Risiken werden nicht nur erkannt, sondern aktiv entschärft. Gesunde Langlebigkeit, Leistungsfähigkeit und Lebensfreude bis ins hohe Alter sind kein Zufall – sie sind planbar. Prävention ist der wahre Luxus.
Weitere Informationen unter: alpstein-clinic.ch

Prof. Dr. Beatrice Beck Schimmer
«Die
ist ein Feld, auf dem bahn-
Die Schweizer Gesundheitsversorgung gilt als eine der besten der Welt. Dennoch stehen auch hierzulande Herausforderungen an. Prof. Dr. Beatrice Beck Schimmer, Direktorin der Universitären Medizin Zürich (UMZH), spricht über das Zusammenspiel von Forschung und Praxis, die Bedeutung von KI in der Medizin – und erklärt, warum «massgeschneiderte» Therapien die Zukunft sind.
Interview SMA Bild Universität Zürich; Frank Brüderli
Frau Beck Schimmer, wie beurteilen Sie als Fachperson die Gesundheit der Schweizer Bevölkerung? Oder anders gefragt: Wie geht es «Herrn und Frau Schweizer»?
Glücklicherweise dürfen wir den Gesundheitszustand der Menschen in der Schweiz als sehr gut bezeichnen. Dies haben wir nicht zuletzt unserem hochstehenden Gesundheitssystem zu verdanken. Dennoch stehen wir, wie überall auf der Welt, auch in der Schweiz vor Herausforderungen. Eine davon ist die wachsende Zahl an Krebserkrankungen, die direkt mit der höheren Lebenserwartung unserer Gesellschaft zusammenhängt. Abgesehen vom menschlichen Leid für die Betroffenen und ihr Umfeld stellt Krebs auch eine enorme ökonomische Herausforderung dar. Aus diesem Grund haben wir es uns bei der Universitären Medizin Zürich (UMZH) zur Aufgabe gemacht, die sogenannte «Präzisionsmedizin» durch gezielte medizinische Forschung zu stärken – insbesondere in der Onkologie.
Was versteht man unter «Präzisionsmedizin»?
Es handelt sich dabei um einen Sammelbegriff für datengetriebene und massgeschneiderte Therapien, die auf ein Individuum oder eine kleinere Gruppe von Menschen zugeschnitten sind. Der grosse Vorteil dieses personalisierten Ansatzes besteht darin, dass er idealerweise zu einer besseren Wirksamkeit bei weniger Nebenwirkungen führt.
Die UMZH hat sich ebenfalls auf die Fahne geschrieben, ihre Spitzenposition in der Medizin zu stärken. In diesem Zusammenhang betonen Sie die Bedeutung von Kooperation und Koordination. Welche Rolle spielen interdisziplinäre Ansätze in der medizinischen Forschung und Patientenversorgung?
Ohne interdisziplinäre Teams sowie eine enge Zusammenarbeit würde die moderne Medizin überhaupt nicht funktionieren. Das wird bei der Präzisionsmedizin besonders augenfällig: Hierfür benötigen wir nicht nur Ärztinnen und Ärzte, sondern auch Fachleute aus der Informatik, der Grundlagenforschung, dem Datenmanagement, der Pflege sowie der Physiotherapie. Diese synergistische Zusammenarbeit ist ein essenzieller Aspekt unserer Arbeit.
Der Volksmund kennt den Spruch «Zu viele Köche verderben den Brei». Trifft das irgendwann auch auf die Medizin zu? Nein, im Gegenteil: Die Expertise vieler Fachleute eröffnet neue Möglichkeiten. Es ist allerdings in der Tat eine Herausforderung, diese interdisziplinäre Zusammenarbeit zu koordinieren, wofür auch entsprechende Fördermittel benötigt werden. Um diesen Herausforderungen zu begegnen, haben wir unter anderem mit ‹The LOOP Zurich› ein translationales Forschungszentrum geschaffen, das sich auf die Präzisionsmedizin konzentriert. Es vereint die biomedizinische Grundlagenforschung und Bioinformatik der ETH Zürich und der Universität Zürich mit der klinischen Forschung von vier universitären Spitälern. Dieses Modell erleichtert es uns auch, die notwendigen Förderbeträge zu beschaffen, um in der Präzisionsmedizin eine führende Position einzunehmen – stets zum Wohle der Patientinnen und Patienten. Sie setzen sich auch aktiv für die Nachwuchsförderung ein, insbesondere von Frauen. Welchen spezifischen Herausforderungen begegnen junge Ärztinnen und Wissenschaftlerinnen heute? Wir haben in der Tat zu wenig Nachwuchs bei den klinischen Forschenden, den Clinical Scientists. Ich kann aus eigener Erfahrung sagen, wie anspruchsvoll es ist, quasi zweigleisig zu fahren. Also einerseits eine Facharztausbildung im Spital zu absolvieren und andererseits eine akademische Laufbahn an der Universität zu verfolgen. Ich habe selbst Forschung und Lehre betrieben und war zugleich als leitende Ärztin der Anästhesiologie des Universitätsspitals Zürich im OP tätig. Für Frauen wird dieser Weg durch die Familienplanung zusätzlich erschwert, was ich ebenfalls aus eigener Erfahrung kenne. Deshalb versucht die Universität Zürich, Frauen aktiv zu unterstützen. Die Kernfrage lautet, wie wir weibliche Clinical Scientists fördern können. Möglichkeiten ergeben sich unter anderem durch geschützte Forschungszeiten, Mentoringangebote sowie durch die Vermittlung von Selbstführungskompetenzen.

Meine Philosophie gilt aber unabhängig von der Jahreszeit: Gesund essen, Sport treiben, ausreichend schlafen sowie für einen guten Ausgleich zur Arbeit sorgen.
– Prof. Dr. Beatrice Beck Schimmer
Warum ist die Rolle der Clinical Scientists so zentral?
Weil diese Ärztinnen und Ärzte die Ideen und Inspirationen aus ihrem medizinischen Alltag direkt in die Forschung tragen, um zum Beispiel Krankheitsursachen zu erkennen, bessere Operationstechniken zu entwickeln oder neue Behandlungsmethoden zu finden. Auf diese Weise können wir neben Grundlagenforschung auch klinische Forschung betreiben, die sich an den realen Bedürfnissen der Menschen orientiert.
Das Laufbahnförderungsprogramm «Filling the gap» der Medizinischen Fakultät der Universität Zürich feiert in diesem Jahr bereits sein zehnjähriges Jubiläum. Wie kam es zu diesem Programm?
Es entstand aus der Erkenntnis heraus, dass es in der Medizinischen Fakultät zu wenig Professorinnen gab. Obwohl rund 60 Prozent der Medizinstudierenden weiblich sind, öffnet sich die Geschlechterschere nach der PostdocPhase stark. Seit 2018 konnten wir den Frauenanteil unter den Professuren, ohne Assistenzprofessuren, von acht auf mittlerweile 19 Prozent erhöhen, also mehr als verdoppeln. Das ist zwar erfreulich, aber wir haben unser Ziel noch nicht erreicht und bleiben hier weiter aktiv am Ball.
Die Digitalisierung verändert die Medizin rasant. Wie beeinflusst dieser Wandel die Ausbildung von Studierenden sowie die tägliche Arbeit von Ärztinnen und Ärzten? Der Wandel ist klar spürbar. Gerade in der Administration im klinischen Alltag stellt die Digitalisierung einen enormen Vorteil dar. Aber auch in der Patientenversorgung ergeben sich grosse Chancen, da Patientinnen und Patienten einfache Informationen selbst abfragen
können. So lässt sich die Zeit, die sie mit ihren Ärztinnen und Ärzten verbringen, intensiver für tiefgehende Gespräche nutzen, anstatt dass einfach Standarddaten erhoben werden. Die Frage, wie wir diese Entwicklung ins Medizinstudium integrieren können, beschäftigt uns ebenfalls sehr. Wir tauschen uns dazu auch mit unseren Partnerinstitutionen aus. Und natürlich ist das Potenzial von KI in der Forschung gewaltig. Grosse Datensätze, die quasi das Fundament für die Präzisionsmedizin bilden, eignen sich perfekt für den Einsatz von KI. Im Rahmen unseres ‹TumorProfilerProjekts› wiederum wollen Forschende den Krebs bei jeder betroffenen Person bis auf Zellebene verstehen. Dazu werden sieben Forschungsplattformen eingesetzt, die innerhalb kurzer Zeit Therapievorschläge unterbreiten, die dann im ‹Tumorboard› von Fachärztinnen und Fachärzten diskutiert werden. Auch hier bietet KI enormes Potenzial.
Ihre Karriere erstreckt sich von der Humanmedizin über die Grundlagenforschung bis zur Führungsposition. Welchen Rat würden Sie Studierenden geben, die über eine ähnliche Laufbahn nachdenken? Man muss vor allem Freude an dem haben, was man tut. Es wird immer schwierige Phasen geben, in denen Selbstmotivation wichtig ist. Wer den Weg des Clinical Scientist einschlägt, muss mit Stress und Enttäuschungen umgehen können, sollte aber auch die Abwechslung schätzen. Enthusiasmus ist dabei unerlässlich. Ausserdem sollte der eigene Weg geplant werden, aber man sollte offen für Unerwartetes bleiben und immer einen Plan B haben. Zudem ist es wichtig zu akzeptieren, dass nicht alles gleichzeitig machbar ist und eine solche Laufbahn länger dauern kann, als wenn man
sich für eine Richtung entscheidet. Generell kann ich sagen: Seid mutig und geht auch mal ein Risiko ein! Der Herbst hat Einzug gehalten. Welches sind nun die gesundheitlichen Risiken und wie kann man diesen proaktiv entgegenwirken? Im Herbst und Winter nehmen Depressionen und Infektionen häufiger zu. Meine Philosophie gilt aber unabhängig von der Jahreszeit: Gesund essen, Sport treiben – ich spiele leidenschaftlich gern Tennis – ausreichend schlafen sowie für einen guten Ausgleich zur Arbeit sorgen. Wo sehen Sie die grössten Chancen für bahnbrechende medizinische Entdeckungen in den nächsten zehn Jahren und welche Rolle spielt die UMZH dabei? Zweifellos in der Präzisionsmedizin! Ich denke, wir stehen hier vor einer enormen Entwicklung mit gewaltigem Potenzial. Das ist das Feld, auf dem bahnbrechende Entdeckungen stattfinden werden. Das bereits erwähnte TumorProfilerProjekt ist ebenfalls enorm spannend. Besonders in der Onkologie passiert sehr viel, aber auch in den Bereichen Mental Health und bei rheumatischen Erkrankungen sehen wir aufregende Chancen. Ein persönliches Steckenpferd von mir, die Gendermedizin, ist ebenfalls ein Teil der Präzisionsmedizin. Zum Beispiel, wenn es um unterschiedliche Schmerzempfindungen von Frauen und Männern geht. Sie sehen, es fehlt nicht an aufregenden Themen und spannenden Chancen, mit denen wir die Gesundheit der Menschen hoffentlich nachhaltig verbessern können.
Über Beatrice Beck Schimmer
Beatrice Beck Schimmer ist seit August 2018
Direktorin der Universitären Medizin Zürich und gehört der siebenköpfigen Universitätsleitung der Universität Zürich an. Sie studierte Humanmedizin an der Universität Bern und habilitierte im Jahr 2003 an der Universität Zürich. Von 2005 bis 2018 arbeitete sie als leitende Ärztin am Universitätsspital Zürich und ab 2009 zusätzlich als ordentliche Professorin für Anästhesiologie, wo sie in der Grundlagenforschung und in der klinischen Forschung tätig war. Von 2012 bis 2018 war sie Mitglied des nationalen Forschungsrats des Schweizerischen Nationalfonds und seit 2011 setzt sie sich aktiv für die Nachwuchsförderung, vor allem für die Karriereplanung von Frauen ein.
AsFam AG
Pflegende Angehörige sind das unsichtbare Rückgrat unseres Gesundheitssystems. AsFam unterstützt sie mit Fachwissen und Herz. Kenny Kunz, Mitglied der Geschäftsleitung bei AsFam, erzählt, was der privaten Spitex wichtig ist und wie sie sich von anderen Anbietern unterscheidet.

Herr Kunz, eine Frage vorab: Würde unser Schweizer Gesundheitswesen überhaupt ohne pflegende Angehörige funktionieren? Nein. Pflegende Angehörige kümmern sich um Familienmitglieder, die langfristig gepflegt werden müssen. Sie sind oft Tag und Nacht im Einsatz. Dabei übernehmen sie Aufgaben, die sonst Pflegefachpersonen leisten müssten, und entlasten Spitäler, Heime und andere Einrichtungen erheblich. Unser Gesundheitswesen profitiert nicht nur von der Arbeit pflegender Angehöriger – es ist auf sie angewiesen.
AsFam wurde 2019 gegründet. Kann man Ihre Firma als Pionierin der Branche bezeichnen?
AsFam war eine der ersten auf Angehörigenpflege spezialisierten SpitexOrganisationen in der Schweiz. Erst seit einem Bundesgerichtsentscheid von 2019 sind pflegende Angehörige berechtigt, sich für Grundpflegeleistungen entlöhnen zu lassen – vorausgesetzt, sie sind bei einer Spitex angestellt. Wir haben diesen Weg von Anfang an mitgeprägt.
Die AsFam betont, sie sei «von pflegenden Angehörigen für pflegende Angehörige». Was bedeutet das?
AsFam wurde aus eigener familiärer Erfahrung
gegründet: Meine Mutter pflegte zuerst mit meiner Grossmutter meinen Grossvater, später allein – und nach einem Unfall auch mich, ohne fachliche oder finanzielle Unterstützung. Mein Vater und ich waren überzeugt, dass pflegende Angehörige mehr Anerkennung und Unterstützung verdienen. So entstand die Vision von AsFam, ihre Lebensqualität und die ihrer Familien nachhaltig zu verbessern.
Die Motivation von AsFam ist, pflegenden Angehörigen eine gewisse Normalität in ihrem Alltag zurückzubringen. Wie schaffen Sie das? Der Alltag pflegender Angehöriger ist alles andere als «normal». Unsere Aufgabe ist es, diese Familien in ihrer wichtigen Rolle im Gesundheitssystem bestmöglich zu unterstützen. Wir beraten sie fachlich, begleiten sie persönlich und entlöhnen ihre Pflegearbeit fair. So können sie sich um ihre Liebsten kümmern, ohne auf professionelle Hilfe und finanzielle Sicherheit verzichten zu müssen.
Wie sieht der Weg aus, um aus pflegenden Angehörigen zertifizierte Pflegehelferinnen und -helfer zu machen?
Viele kümmern sich seit Jahren um ihre Familienmitglieder, verfügen aber meist nicht über eine formelle Qualifikation. Für SpitexMitarbeitende ist diese jedoch gesetzlich vorgeschrieben. Die pflegerische Grundbildung wird von uns finanziert, stärkt die Pflegekompetenz und fördert eine qualitativ hochwertige Pflege.
Kommen wir zu den Schattenseiten Ihrer Branche: Leider tummeln sich hier viele unseriöse
Anbieter. Das hat dazu geführt, dass der Kanton Zürich die Finanzierungszuschüsse um 50 Prozent reduziert hat. Was bedeutet das für AsFam? Die Restkostenkürzung im Kanton Zürich ist für uns ein klares Signal gegen Organisationen,
die auf Profit ausgerichtet sind. Wir begrüssen diese Entwicklung – sie stärkt Organisationen wie AsFam, die mit Verantwortung und aus echter Überzeugung handeln. Natürlich werden auch wir die Kürzung spüren. Wir sehen darin aber keine Bedrohung, sondern die Gelegenheit, zu zeigen, dass wir es ernst meinen.
Immer wieder hört und liest man, dass private Spitexanbieter überhöhte Tarife haben und nur wenig Geld davon zu pflegenden Angehörigen fliesst. Dabei sei unklar, wofür der dadurch entstehende Gewinn verwendet würde. Wie können Sie dazu Stellung nehmen? AsFam hat wie jede andere Pflegeorganisation Aufwände für ihre Tätigkeit. Darunter beispielsweise Lohn und Sozialversicherungskosten, Kosten für Leitung und Administration oder interne Betriebskosten. Gemäss dem Krankenversicherungsgesetz vergüten die Krankenkassen für die erbrachte Grundpflege durch pflegende Angehörige einen schweizweit einheitlichen Stundenansatz von Fr. 52,60. Dieser Betrag deckt jedoch nicht alle unsere Kosten ab. Die verbleibenden Restkosten werden durch die öffentliche Hand getragen. Die Unterstützung variiert je nach Kanton, teilweise beläuft sich der Betrag auf null Franken. Überschüsse werden verantwortungsvoll und zweckgebunden reinvestiert – zum Beispiel in den Ausbau und die Qualität der Angebote für pflegende Angehörige oder in deren Vertretung gegenüber Gemeinden, Kantonen und Behörden. Das Ziel der AsFam ist es, die Lebensqualität pflegender Angehöriger und ihrer Familien zu verbessern, indem sie diese persönlich begleiten, kompetent beraten und professionell unterstützen. Dabei stehen die pflegenden Angehörigen im Mittelpunkt – nicht die Gewinnmaximierung.
Was motiviert Sie persönlich jeden Tag, Ihrer Arbeit nachzugehen? Meine Familie. Was sie selbst in der Pflege meines Grossvaters geleistet hat, hat mich tief geprägt und mir gezeigt, wie wichtig echte Unterstützung für pflegende Angehörige ist. Genau deshalb setze ich mich mit ganzem Herzen für AsFam ein – nicht, um die ganze Welt zu verändern, sondern um die Welt vieler Menschen zumindest ein Stück besser zu machen.
AsFam ist ein Familienunternehmen und wurde nach einer persönlichen Pflegeerfahrung in der Familie gegründet – mit dem Ziel, pflegende Angehörige zu unterstützen, zu stärken und ihnen echte Anerkennung zu geben. Diese familiären Wurzeln prägen das Handeln: Nähe, Vertrauen und Verständnis stehen bei AsFam im Zentrum. Die private Spitexorganisation begleitet pflegende Angehörige persönlich, beratet sie fachlich und entlöhnt sie fair inkl. 60-Prozent-Pensionskassenbeitrag ab dem ersten Tag. AsFam setzt auf regionale Strukturen statt zentraler Organisation sowie auf Fachkompetenz – und Herz. www.asfam.ch
abrakazahbra ag • Brandreport
Der Beweis, dass ein Zahnarztbesuch etwas Magisches sein kann
Ein Zahnarzttermin löst bei vielen Menschen Unbehagen aus. Doch bei Yeliz Gross und ihrer Praxis abrakazahbra ag ist ein solcher Besuch eine positive Erfahrung – dank Empathie, persönlicher Zuwendung sowie einem starken Fokus auf Vertrauen.

Frau Gross, wie kamen Sie darauf, Ihre Praxis abrakazahbra ag zu nennen?
Dieser Name ist uns sehr wichtig, weil er genau das ausdrückt, was wir erreichen wollen: Er weckt Assoziationen mit etwas Wundersamem, mit Magie. Viele Menschen kommen mit Ängsten in eine Zahnarztpraxis. Wir aber möchten diese Sorgen verschwinden lassen und stattdessen eine positive und fast schon «zauberhafte» Erfahrung schaffen. Für uns ist es wie Magie, wenn Patientinnen oder Patienten, die ängstlich hereinkommen, uns mit einem strahlenden Lächeln und ohne Angst wieder verlassen. Doch nicht nur das – auch unsere sozialverträglichen Preise sind Teil der Magie. Tatsächlich sind die Kosten für viele eine Hürde, wenn es um Zahnbehandlungen geht. Wie setzen Sie sich für bezahlbare Preise ein und warum ist Ihnen das so wichtig? Wir glauben, dass hochwertige Zahnmedizin für alle zugänglich sein sollte. Daher optimieren wir unsere internen Abläufe, um unnötige Kosten zu vermeiden, und setzen auf eine faire Preisgestaltung. So möchten wir verhindern, dass Menschen aus finanziellen Gründen notwendige Behandlungen aufschieben. Unsere Priorität ist nicht der Profit, sondern das Wohlergehen der Patientinnen und Patienten. Hier wird konsequent auf Überbehandlungen verzichtet. Die Leistungen erfolgen zum Sozialtarif, Ratenzahlungen sind selbstverständlich möglich. Das Ziel: ethisch vertretbar, höchste Qualität, faire Preise – und nie Kompromisse
bei den Materialien. So entsteht Vertrauen, das Patientinnen und Patienten nachhaltig spüren.
Im heutigen Gesundheitssystem dominieren oft Zeitdruck und Bürokratie. Wie schaffen Sie es in Ihrer Praxis, einen Gegenpol dazu zu bilden?
Für uns ist die Menschlichkeit keine Floskel, sondern bildet das Fundament unserer Arbeit. Wir erleben täglich, dass sich Patientinnen und Patienten oftmals wie eine Nummer im medizinischen Gefüge vorkommen. Bei uns beginnt daher die persönliche Betreuung schon am Telefon: Ich nehme mir die Zeit, meinem Gegenüber wirklich zuzuhören und die Anliegen zu verstehen, bevor überhaupt ein Termin vereinbart wird. Wir möchten, dass sich jede Patientin und jeder Patient von Anfang an wohl und ernst genommen fühlt.
Worauf legen Sie bei der persönlichen Beratung besonders Wert?
Der wichtigste Faktor besteht meiner Erfahrung nach darin, eine Atmosphäre des Vertrauens zu schaffen. Viele Menschen kommen mit Ängsten in eine Zahnarztpraxis. Wir möchten diese Sorgen zerstreuen, indem wir jede Behandlung transparent und verständlich erklären. Es geht also nicht nur darum, eine medizinische Lösung zu präsentieren, sondern gemeinsam mit der Patientin oder dem Patienten den besten Weg zu finden. Eine Behandlung soll nicht einfach «abgehakt» werden, sondern eine gemeinschaftliche Entscheidung sein.
Wie nehmen Sie speziell Kindern die Angst vor dem Zahnarztbesuch?
Kinder sind besonders sensibel. Wir begegnen ihnen daher mit viel Einfühlungsvermögen. Bei uns gibt es kein Drängen. Wir erklären altersgerecht, was wir tun, und binden die Kinder spielerisch in den Ablauf ein. Manchmal ist es nur ein kurzes Gespräch über ihr Lieblingstier oder eine kleine Geschichte, um die Stimmung aufzulockern. Auf diese Weise geben wir ihnen das Gefühl, die Kontrolle über die

Situation zu haben. Es ist oft eine grosse Erleichterung für die Eltern, zu sehen, wie ihre Kinder plötzlich lachen, anstatt sich nervös zu winden.
Zum Schluss: Haben Sie zahnmedizinische Tipps für unsere Leser?
Wir nehmen wahr, dass der Zahnarzt häufig gewechselt wird. Wir empfehlen, möglichst beim gleichen Zahnarzt zu bleiben – sei es bei uns oder bei einem anderen. Für die Dokumentation der Krankengeschichte, für die Beobachtung der Zähne ist eine Beständigkeit das A und O. Insbesondere bei Parodontose ist es wichtig, dass die Dentalhygienikerin immer dieselbe ist, denn nicht der Ist Zustand ist ausschlaggebend, sondern die Veränderung über die Zeit.
Weitere Informationen unter: abrakazahbra.ch
Mit dem Rabattcode «Fokus 01» erhalten Leserinnen und Leser eine Ermässigung von 15 Prozent auf alle Zahnbehandlungen. Gültig bis 20. November 2025. Den Code bitte bei der telefonischen Anmeldung nennen.
abrakazahbra ag Alfred-Escher-Strasse 11 8002 Zürich +41 44 461 16 16
Zur Person
Yeliz Gross ist die Geschäftsführerin der abrakazahbra ag und das Gesicht der Praxis: Sie kümmert sich mit Herz und Leidenschaft um die Patientinnen und Patienten – vom Erstkontakt am Telefon, wo sie ohne Zeitdruck stets freundlich berät, über die Betreuung vor Ort bis hin zum administrativen Abschluss der Behandlung.

Wenn Erschöpfung mehr ist als Stress – Wege aus der Depression
Depressionen gehören zu den häufigsten psychischen Erkrankungen. Wer sie mit Willensschwäche verwechselt, übersieht die Ernsthaftigkeit. Denn ohne Hilfe kann sich der Zustand verschlimmern – bis hin zu Suizidgedanken.

Prof. Dr. med. Marc Walter
Leiter und Chefarzt Klinik für Psychiatrie und Psychotherapie, Psychiatrische Dienste Aargau
Herr Walter, ich fühle mich seit Tagen müde, mag am Wochenende nichts mehr unternehmen. Habe ich womöglich Burn-out oder sogar eine Depression? Müdigkeit, Lustlosigkeit und der Rückzug aus sozialen Aktivitäten können tatsächlich erste Signale für ein Burnout sein – aber ebenso für eine Depression. Beim Burnout steht in der Regel die Erschöpfung im Zentrum, ausgelöst durch eine lang anhaltende Belastung am Arbeitsplatz. Betroffene fühlen sich ausgelaugt, haben kaum mehr Energie und das Gefühl, den täglichen Anforderungen nicht mehr gewachsen zu sein.
Bei einer Depression sind die Symptome hingegen umfassender und meist schwerwiegender: Betroffene haben eine gedrückte depressive Stimmung, verlieren die Freude an fast allen Dingen, sind hoffnungslos, leiden manchmal unter Konzentrationsstörungen, Antriebsmangel, vermindertem Selbstwertgefühl und Schlaf oder Appetitstörungen. Während Burnout also eng mit der Arbeitsbelastung verknüpft ist, betrifft eine Depression mit ihren teils schwerwiegenden Symptomen alle Lebensbereiche. In beiden Fällen ist es wichtig, die Beschwerden ernst zu nehmen und medizinisch abklären zu lassen.
Wie findet man denn heraus, was genau vorliegt? Hier hilft eine fachgerechte Diagnostik. Während das Burnout ein arbeitsbezogener Erschöpfungszustand ist, ist die Depression eine eigenständige psychische Störung, die mit einer deutlichen psychosozialen Funktionseinschränkung verbunden ist. Burnout kann aber auch als leichter depressiver Zustand verstanden werden, der sich zu einer Depression entwickeln kann. Bei der Diagnosestellung schauen Ärztinnen und Therapeuten generell, welche depressiven Symptome auftreten, wie lange sie bestehen, in welchen Situationen sie beschrieben werden und ob weitere Beschwerden wie Schlaf oder Appetitstörungen oder Ängste hinzukommen. Sollten depressive Symptome vorliegen, ist es wichtig, auch nach Suizidgedanken zu fragen, die bei einer schweren Depression häufig auftauchen. Entscheidend ist zudem, dass die Symptome mindestens zwei Wochen anhalten müssen, um eine Depression zu diagnostizieren.
Was bedeutet das konkret für Betroffene?
Je nach Schweregrad gibt es verschiedene Möglichkeiten. Bei leichten Beschwerden kann schon eine
Eine Depression ist keine Willensschwäche, sondern eine ernsthafte psychische Krankheit. Wer versucht, sich «zusammenzureissen» und weiterzumachen, obwohl er oder sie längst erschöpft ist, läuft Gefahr, dass sich der depressive Zustand weiter verschlechtert.
– Prof. Dr. med. Marc Walter, Leiter und Chefarzt Klinik für Psychiatrie und Psychotherapie
ambulante Psychotherapie helfen, ergänzt durch Veränderungen im Alltag – etwa mehr Bewegung, geregelte Tagesstrukturen oder bewusst geplante Erholungsphasen. Bei mittelgradigen Depressionen sind oft auch Medikamente begleitend zu einer Psychotherapie sinnvoll. Bei schweren Depressionen sollten, wenn möglich, immer antidepressive Medikamente eingenommen werden. Wenn die Belastung sehr hoch ist und die Symptome schwer ausgeprägt sind, ist ein stationärer Aufenthalt der richtige Schritt. Dort können Betroffene Abstand zu den Stressfaktoren gewinnen, Körper und Seele kommen zur Ruhe, und sie erhalten professionelle Unterstützung in Einzel und Gruppentherapien. Wichtig ist: Sowohl Burnout als auch Depression sind sehr gut behandelbar – vorausgesetzt, man wartet nicht zu lange, sondern sucht frühzeitig Hilfe.
Im Alltag hört man häufig Sätze wie «Reiss dich doch zusammen» oder «Das geht schon wieder vorbei». Warum ist diese Haltung problematisch?
Weil sie die Erkrankung verharmlost. Eine Depression ist keine Willensschwäche, sondern eine ernsthafte psychische Krankheit. Wer versucht, sich «zusammenzureissen» und weiterzumachen, obwohl er oder sie längst erschöpft ist, läuft Gefahr, dass sich der depressive Zustand weiter verschlechtert. Manche entwickeln Suizidgedanken oder psychotische Symptome. Diese Haltung kann also gefährlich sein. Wir würden auch niemandem mit einem gebrochenen Bein raten: «Lauf doch einfach weiter.»
Wann sollten Angehörige hellhörig werden?
Wenn jemand über mehrere Wochen hinweg deprimiert ist, ständig müde oder hoffnungslos wirkt, sich vermehrt zurückzieht oder die Person auch gereizt und dünnhäutig ist, den Alltagsstress nicht
mehr aushält, sollte man aufmerksam werden. Dann empfiehlt sich zunächst der Gang zum Hausarzt oder zur Hausärztin. Bei schwereren depressiven Symptomen ist eine direkte Konsultation bei einer ambulanten Psychiaterin oder einem ambulanten Psychiater angezeigt. Sollten ernsthafte Suizidgedanken hinzukommen, sollte der psychiatrische Notfall aufgesucht werden und ein Klinikeintritt erfolgen. Sie haben erwähnt, dass frühe Hilfe entscheidend ist. Wie bekommt man diese, wo man doch immer wieder von langen Wartezeiten hört?
Genau dafür haben wir die neue, auf Depressionen spezialisierte Station geschaffen. Patientinnen und Patienten können dort rasch und unkompliziert aufgenommen werden – ohne vorgängige lange Abklärungen oder Wartezeiten. Unser Ziel ist es, schnelle Hilfe anzubieten, wenn die Belastung besonders gross ist. Wer sich bei uns meldet, erhält zeitnah einen Platz. Alternativ bietet auch die Privatstation Idéa schnelle Unterstützung bei Depressionen, Burnout oder Angststörungen. Sie richtet sich an Patientinnen und Patienten, die Wert auf eine besonders ruhige Umgebung und gehobenen Komfort legen. Worauf kommt es generell bei einem stationären Aufenthalt bei Depressionen an?
Ein stationärer Aufenthalt kann wie eine Auszeit wirken – wie eine Art Reset. Es sollte eine klare Tagesstruktur mit individuell abgestimmtem Therapieplan, zum Beispiel Einzel und Gruppentherapien, Entspannungs und Bewegungseinheiten sowie ergänzenden Angeboten wie Kunst oder Ergotherapie geben. In der ersten Phase sollten die Therapien gut auf den individuellen depressiven Zustand angepasst werden, es sollte nicht zu wenig, aber gerade auch bei der Depression nicht zu viel an Herausforderungen und
therapeutischer Arbeit sein. So können die Betroffenen zunächst zur Ruhe kommen und den Stresslevel reduzieren; Stressfaktoren sollten dann auf ein Minimum reduziert werden, das gilt besonders für äussere Stressfaktoren aus dem Alltag der Betroffenen. Wenn sich der depressive Zustand im Verlauf der Therapie weiter verbessert, wird in der zweiten Phase der Behandlung auf die Neuausrichtung fokussiert: Wie will ich mein Leben künftig ausrichten? Muss ich vielleicht meine Belastungen reduzieren oder meine Prioritäten neu ordnen? Solche Fragen lassen sich in einem stationären Rahmen besser klären. Dabei hilft bei den PDAG nicht zuletzt auch unser grosser Park, der den Patientinnen und Patienten zusätzlich Raum für Erholung und neue Perspektiven bietet. Auch Angehörige leiden stark mit. Welche Unterstützung erhalten sie bei Ihnen? Angehörige spielen im Behandlungsprozess eine wichtige Rolle. Wir beziehen sie in der Regel möglichst früh ein, denn sie können wertvolle Hinweise geben, beispielsweise welche Stressfaktoren aus der Angehörigenperspektive vorliegen, wie sich die Depression entwickelt hat und wo allfällige Probleme liegen. Ausserdem bieten wir Gespräche und Informationen, damit Angehörige lernen, die Erkrankung zu verstehen und besser damit umzugehen. Sie sind Teil des Behandlungsprozesses.
Manche Menschen scheuen sich, professionelle Hilfe in Anspruch zu nehmen, weil sie Angst vor Stigmatisierung haben. Was raten Sie diesen Menschen? Das ist verständlich, aber unbegründet. Depressionen gehören zu den häufigsten psychiatrischen Erkrankungen. Etwa jede fünfte Person ist im Laufe des Lebens betroffen. Der erste Schritt kann bei leichten Symptomen der Besuch beim Hausarzt oder bei der Hausärztin sein – das fällt vielen auch leichter, weil die Hemmschwelle niedriger ist. Dort kann eine erste Abklärung erfolgen. Bei Bedarf wird man weiter zu einer Fachärztin oder einem Facharzt für Psychiatrie überwiesen. Je nach Schweregrad kann auch eine stationäre Behandlung indiziert sein. Wichtig ist: Niemand muss da alleine durch. Weitere Informationen unter: pdag.ch

«Die
Eine frühzeitige augenärztliche Vorsorge ist wichtig, damit bei Kindern eine Sehschwäche rechtzeitig erkannt und behandelt werden kann. Denn im Kindesalter ist vieles noch korrigierbar, was im Erwachsenenalter oft nicht mehr möglich ist. Prof. (UNIC) Dr. med. Johannes P. Eisenack von der Augenklinik Bellevue in Zürich erklärt, worauf es ankommt, damit Kinderaugen gesund bleiben oder werden – und weshalb Kinder zu seinen liebsten Patienten gehören.

Herr Prof. Dr. Eisenack, bevor wir tiefer in die Materie gehen: Wie sind Sie überhaupt darauf gekommen, sich in der Augenheilkunde ausgerechnet auf Kinder zu spezialisieren? Mich haben schon früh zwei Dinge fasziniert: die Komplexität des Auges und die Offenheit von Kindern. In der Kinderophthalmologie kommen beide Seiten zusammen. Medizinisch ist sie ausserordentlich vielseitig – sie reicht von der Vorsorge über Schielbehandlungen bis hin zu operativen Eingriffen. Gleichzeitig geht es aber immer auch darum, Vertrauen zu schaffen, Ängste zu nehmen und spielerisch Lösungen zu finden.
Dazu kommt: Viele Weichen für die Sehfähigkeit eines Menschen werden in den ersten Lebensjahren gestellt. Wenn wir in dieser Zeit eingreifen, können wir viel bewirken – zum Teil mit lebenslanger Wirkung. Dieses Zusammenspiel von fachlicher Herausforderung und unmittelbarer Relevanz für die Entwicklung eines Kindes hat mich von Anfang an begeistert.
Würde man als Elternteil eine Sehschwäche denn überhaupt bemerken? Oder anders formuliert: Welche Anzeichen sind typisch?
In einem Wort: Jein. Es gibt Hinweise, auf die man achten kann: wenn ein Kind sehr nah an Bücher oder Bildschirme herangeht, wenn es häufig stolpert oder über Kopfschmerzen klagt. Auch ein schiefer Kopf beim Malen kann ein Signal sein. Viele Sehschwächen bleiben allerdings lange verborgen, weil Kinder keine Vergleichsmöglichkeit haben. Für sie ist das, was sie sehen, normal; sie nehmen ihre Welt so hin, wie sie sie erleben. Umso wichtiger ist der Blick des Fachmanns: Je früher eine Unregelmässigkeit erkannt wird, desto besser lässt sie sich behandeln. Im Kindesalter ist vieles noch gut korrigierbar, im Erwachsenenalter dann oft nicht mehr. Deshalb sind Vorsorgeuntersuchungen entscheidend – selbst wenn sie am Ende «nur» die Gewissheit bringen, dass alles in Ordnung ist. Als Vater weiss ich, wie wertvoll genau dieses Gefühl ist.
Heisst das, Kinderaugen sollten auch ohne konkreten Verdacht untersucht werden? Ja, meiner Meinung nach wäre das gut. Natürlich gibt es auch Vorsorgeuntersuchungen durch den Kinderarzt und später durch den schulärztlichen Dienst, subtilere Sehfehler benötigen jedoch einen Spezialisten oder eine Spezialistin.
Besonders wichtig ist eine augenärztliche Kontrolle, wenn Risikofaktoren bestehen: etwa eine Frühgeburt, familiäre Vorbelastungen bezüglich SchielErkrankungen oder einem frühen Brillenbedarf, auch bei Entwicklungsverzögerungen. Ein kurzer Termin genügt oft, um Gewissheit zu haben – und im entscheidenden Moment eingreifen zu können. Was genau wird bei einer solchen Untersuchung geprüft?
Insgesamt beurteilen wir die visuelle Entwicklung des Kindes: Stehen die Augen gerade? Können sie einem
Das Gegenmittel ist erstaunlich einfach: Tageslicht und Bewegung im Freien. Studien zeigen, dass schon zwei Stunden draussen pro Tag die Wahrscheinlichkeit für eine Myopie deutlich senken.
– Prof. Dr. med. Johannes P. Eisenack, Ophthalmologe
Das Gegenmittel ist erstaunlich einfach: Tageslicht und Bewegung im Freien. Studien zeigen, dass schon zwei Stunden draussen pro Tag die Wahrscheinlichkeit für eine Myopie deutlich senken. Es geht also nicht darum, digitale Geräte zu verbieten – sie gehören heute zum Alltag. Entscheidend ist der Ausgleich: Bildschirmzeit drinnen, Tageslicht draussen. Und falls dies alleine noch nicht reicht, kann mit speziellen Brillengläsern oder auch Augentropfen das Voranschreiten der Myopie aufgehalten oder zumindest verlangsamt werden. Sie führen selbst auch Augenoperationen durch. Welche sind bei Kindern am häufigsten?
Gegenstand folgen? Liegt eine einäugige oder beidäugige Fehlsichtigkeit vor? Finden sich Auffälligkeiten der Netzhaut, der Sehnerven? Natürlich spielt auch das räumliche Sehen in diesem Entwicklungsstadium eine zentrale Rolle. Viele dieser Untersuchungen lassen sich bereits im Baby oder Kleinkindalter durchführen –unkompliziert und ohne aktive Mithilfe des Kindes. Diese scheinbar einfachen Abklärungen geben uns ein sehr zuverlässiges Bild davon, wie sich die Sehfähigkeit entwickelt – und ob weitere Schritte nötig sind.
Schielen fällt Eltern meist schnell auf. Empfiehlt es sich da, erst einmal abzuwarten –oder sollte man sofort zum Arzt?
Eine Fehlstellung der Augen im frühen Kindesalter sollte stets ernst genommen werden. In den ersten Lebenswochen kann es noch normal sein, wenn die Augen noch nicht immer geradestehen. Hält die Abweichung jedoch an, braucht es unbedingt eine zeitige augenärztliche Abklärung. Viele glauben, Schielen sei nur ein Schönheitsfehler. Stimmt das?
Nein, Schielen ist nicht allein eine Frage der Optik. Bleibt es unbehandelt, kann das betroffene Auge vom Gehirn gewissermassen «ausgeschaltet» werden. Das Kind verliert dadurch auch die Fähigkeit zum beidäugigen, räumlichen Sehen – eine Funktion, die sich nur in den ersten Lebensjahren entwickelt. Wird in dieser Zeit nicht korrigiert, sind die Folgen später kaum mehr reversibel.
Das heisst, man kann Schielen behandeln?
Ja, auf jeden Fall. Entscheidend ist der Zeitpunkt. Je früher wir beginnen, desto besser sind die Chancen, die Sehkraft und auch das beidäugige Sehen vollständig zu erhalten. Die Behandlung hängt von der Art des Schielens ab: Manchmal genügt eine individuell angepasste Brille, manchmal braucht es ergänzend eine sogenannte Okklusionstherapie, also das zeitweise Abkleben des stärkeren Auges. In bestimmten Fällen ist auch eine Operation notwendig, um die Augenmuskeln so zu justieren, dass beide Augen wieder im Einklang arbeiten.
Ein Thema, das die meisten Eltern bewegt, ist die Bildschirmzeit. Wie beeinflusst sie die Gesundheit unserer Kinder?
Die zunehmende Nutzung digitaler Medien hat tatsächlich ernst zu nehmende Folgen. Kinder verbringen heute sehr viel Zeit im Nahbereich – ob mit Handy, Tablet oder Computer. Das Auge passt sich an diese Dauerbelastung an, indem es länger wird. Dadurch entsteht eine Myopie, also eine Kurzsichtigkeit, die sich über die Jahre verstärken kann. Je früher das beginnt, desto höher ist später das Risiko für ernsthafte Augenerkrankungen wie z. B. Netzhautablösungen.
Ich sehe in meiner Praxis immer öfter Kinder, die bereits vor dem ChindsgiStart kurzsichtig sind – etwas, das früher meist erst in der Pubertät auftrat. Die Eltern sind oft erstaunt, wie rasch die Kurzsichtigkeit zunimmt.

Die meisten Eingriffe betreffen das Schielen. Dabei werden die Augenmuskeln so angepasst, dass beide Augen wieder in dieselbe Richtung schauen und das räumliche Sehen oft auch verbessert werden kann. Auch Operationen an den Augenlidern zur Verbesserung der Lidhebung bei sogenannten PtosisErkrankungen können eine Verbesserung der visuellen Entwicklung bringen; Eingriffe an den Tränenwegen verbessern den Abfluss der Tränen. Je nach Situation kann auch eine Operation am Grauen Star im Kindesalter nötig sein – etwa, wenn eine angeborene Linsentrübung die Sehentwicklung blockiert. Ich erinnere mich an ein vierjähriges Kind, das nach einer Schieloperation zum ersten Mal richtig räumlich sehen konnte. Für die Eltern war das ein bewegender, unvergesslicher Moment! Zum Glück sind diese Eingriffe heute sehr schonend und sicher. Kinder sind besondere Patienten. Wie gelingt es Ihnen, dass sie sich bei einer Untersuchung wohlfühlen? Kinder sind für mich die schönsten Patienten. Sie bringen so viel Ehrlichkeit und Lebendigkeit mit – da ist jede Untersuchung einzigartig. Viele können noch gar nicht in Worte fassen, was sie sehen, deshalb braucht es Geduld, Fantasie und eine grosse Portion Humor. Wir arbeiten mit bunten Bildern, Figuren oder Spielen, sodass die Tests wie kleine Abenteuer wirken. Mir ist wichtig, dass die Kinder sich geborgen fühlen. Dies beginnt schon beim Wartezimmer, in dem wir sogar ein echtes Auto und ein Piratenschiff haben; aber auch viele Bücher, Stofftiere und Spiele bringen Ablenkung. Wenn ein Kind anfangs ängstlich ist und am Ende lacht oder stolz erzählt, was es geschafft hat, dann ist das für mich ein grosser Moment. Solche Begegnungen sind der Grund, warum ich meinen Beruf so sehr liebe.
Die Augenklinik Bellevue in Zürich ist eine renommierte Spezialpraxis für Kinderaugenheilkunde. Gegründet von Johannes P. Eisenack, klinisch assoziierter Professor an der Universität Nikosia, bietet sie umfassende diagnostische, konservative und operative Behandlungsmöglichkeiten für die visuellen Bedürfnisse der Kleinsten.
www.augenklinik-bellevue.ch


Die Bauchmuskeln müssen bei einer Schwangerschaft auseinanderweichen, um der Gebärmutter Platz zu machen. Weniger bekannt ist, dass sich dieser Spalt im Nachhinein oft nicht mehr normalisiert. Daraus kann eine bleibende Rektusdiastase entstehen, die mit erheblichen Beschwerden für die Betroffenen verbunden ist. Auch hier gilt: Früherkennung und Behandlung ersparen viel Leid.
Um zu verstehen, was eine Rektusdiastase ist, muss man sich das Anatomiebuch ins Gedächtnis rufen. Im Bauchraum verlaufen zwei Stränge der geraden Bauchmuskeln von den Rippen bis zum Becken. Zwischen diesen Muskeln befindet sich ein schmaler Spalt von wenigen Millimetern: die Linea alba. Eine Rektusdiastase entsteht, wenn die geraden Bauchmuskeln nach links und rechts wegdriften und sich so der Spalt dazwischen ausweitet. Diese Lücke bringt eine Instabilität der Bauchwand mit sich, was sich schlussendlich in vielfältigen Symptomen und ernst zu nehmenden Komplikationen bemerkbar machen kann.
Bewertung der Rektusdiastase
Wie viele Erkrankungen werden auch Rektusdiastasen in Schweregraden bewertet. In der Literatur geschieht dies zurzeit nur auf Basis der messbaren Breite der Lücke zwischen den beiden geraden Bauchmuskeln. Wie eingangs erwähnt, sind wenige Millimeter als normal zu bewerten und stellen keinen Befund dar. Die Diastase wird als erstgradig angesehen, wenn die Muskeln bis zu drei Zentimeter auseinandergewichen sind. Bis fünf Zentimeter stellt den zweiten Grad dar, alles darüber wird dem dritten Grad zugeordnet.
Die Symptome fliessen derzeit noch nicht in diese Bewertung ein, da es in der weltweiten Literatur bis anhin keinen Konsens darüber gibt, welche Symptome zu welchem Schweregrad gehören. So weit ist die Medizin noch nicht, allerdings wird viel in die Erforschung der Muskulatur investiert. Entsprechend gab es in den letzten Jahrzehnten bereits einige Fortschritte in der Behandlung von Rektusdiastasen. Beispielsweise sind heutzutage auch minimalinvasive anstelle von grossen und offenen Eingriffen möglich.
Cleverer Trick mit Tücken
Eigentlich hat die Natur die Bauchmuskulatur schlau angeordnet. Mit der Linea alba und ihren elastischen Eiweissfäden zwischen den geraden Bauchmuskeln enthält der Körper eine Dehnungsfuge. So können die Bauchmuskeln bei einer Schwangerschaft

auseinanderweichen und der Gebärmutter und dem Kind Platz verschaffen. Nach der Geburt ziehen sich die Fasern wieder zusammen, die Muskeln kommen in die Mitte zurück und die Stabilität wird wiederhergestellt. In den meisten Fällen tritt nach wenigen Monaten bis zu einem Jahr eine Normalisierung ohne dauerhafte Beschwerden ein. Zuweilen, insbesondere bei mehrfacher Schwangerschaft, verlieren die Fasern den Kontakt zueinander und lassen sich nicht mehr verbinden. Daraus kann sich eine bleibende Rektusdiastase bilden. Allerdings besteht das Risiko nicht nur bei einer Schwangerschaften; Frauen sowie Männer können unabhängig davon eine solche Diastase entwickeln. Einerseits kann eine Rektusdiastase angeboren sein, beispielsweise durch Bindegewebsstörungen. Andererseits spielen auch körperliche Belastungen und Gewichtsschwankungen eine Rolle. Signifikante Zuund Abnahmen des Körpergewichts sowie Körperbelastungen können zu Rissen in der Faserstruktur und später zu Rektusdiastasen führen. Die Ursache ist für sich nicht ausschlaggebend für den Behandlungserfolg, vielmehr ist es wichtig, frühzeitig zu handeln.
Vielschichtige Beschwerden
Die Stabilität der Bauchwand ist aus mehreren Gründen essenziell, weshalb sich Rektusdiastasen durch unterschiedliche Symptome bemerkbar machen können. Oftmals gehen damit Rückenschmerzen als Hauptsymptom einher. Da vorne die Stabilität nicht mehr gegeben ist, kann das zu einer Fehlbelastung der Rückenmuskulatur führen. Es kann aber auch an der Körpervorderseite zu Komplikationen kommen, wenn in der Diastase viele Brüche hintereinander entstehen. Zum einen kann dies Schmerzen und Nervenreizungen hervorrufen. Zum anderen können durch diese Löcher Fett aus dem Bauchraum sowie dem Dünndarm austreten. Dies kann wiederum zu Einklemmungserscheinungen und Verdauungsproblemen führen.
Bei anderen Patient:innen sind die Auswirkungen kosmetischer Natur. Der Bauch steht deutlich hervor und sieht stark «aufgebläht» aus. Das mag zwar harmlos klingen, kann aber mit erheblichen psychischen Belastungen einhergehen. Das Körperund Selbstbewusstsein leiden stark. Frauen in dieser Situation werden regelmässig darauf angesprochen,
wann denn das nächste Kind komme. Dies, obwohl die Geburt schon Wochen oder Monate zurückliegt. Auf Dauer geraten die Betroffenen in eine Position erhöhten psychischen Leidensdrucks und die Diastase wird zu einer alltäglichen Belastung.
Diagnose und Behandlung
Einen Erstverdacht auf eine Rektusdiastase kann man selbst zu Hause testen. Ein erstes Indiz ist, dass sich der Bauch merklich nach vorne wölbt, auch bei schlanker Statur. Ein weiterer Selbsttest besteht darin, sich auf den Rücken zu legen und, ohne sich abzustützen, leicht aufzusetzen. Bei einer Rektusdiastase wölbt sich der Bauch vom Brustbein bis zum Nabel kielartig vor, ähnlich einem umgekehrten Bootsrumpf. Verhärtet sich durch diesen Test der Verdacht, empfiehlt es sich, eine Fachperson aufzusuchen. Durch Abtasten, Übungen und Ultraschall können eine Rektusdiastase und allfällige bereits eingetretene Brüche klinisch diagnostiziert werden. Auf diese Weise kann die optimale Behandlungsstrategie individuell festgelegt werden. Bei Schwangeren und Frauen, die geboren haben, ist wichtig, dass sie den Empfehlungen von Hebammen folgen und nach der Geburt die Rückbildungsgymnastik durchführen. Dies wirkt sowohl präventiv als auch wiederherstellend auf die schräge und gerade Bauchmuskulatur. Unabhängig von einer Schwangerschaft reichen in vielen Fällen Physiotherapien aus, um die Stabilität der Bauchwand herbeizuführen und ein beschwerdefreies Leben zu ermöglichen. Falls sich die Rektusdiastase nicht verbessert – oder gar schlimmer wird – kann ein operativer Eingriff in Betracht gezogen werden. Mittlerweile werden Rektusdiastasen nicht mehr «nur» als kosmetisches Problem eingestuft. Im Regelfall werden operative Behandlungen von Rektusdiastasen von über drei Zentimetern und mit bestimmten Symptomen von den Krankenkassen übernommen.
Text Kevin Meier

Jetzt Gratismuster bestellen
Blasenzentrum der Frau AG

Harninkontinenz betrifft viele Frauen – und dennoch sprechen nur wenige darüber. Aus Scham oder aus Sorge, nicht ernst genommen zu werden, zögern Betroffene oft, ärztliche Hilfe in Anspruch zu nehmen. Dabei gibt es heute effektive Behandlungsmöglichkeiten. Im «Blasenzentrum der Frau» in Frauenfeld schaffen erfahrene Fachärztinnen und Fachärzte einen geschützten Rahmen, in dem Beschwerden offen angesprochen und individuell behandelt werden können.
Belastung oder Drang –die beiden Hauptformen
Die häufigsten Formen der Inkontinenz sind die Belastungsinkontinenz und die Dranginkontinenz:
– Belastungsinkontinenz: Urinverlust, wenn Druck auf den Bauchraum entsteht – etwa beim Husten, Niesen, Lachen oder beim Sport. Die Ursache ist eine Schwäche des Beckenbodens und/oder des Harnröhrenverschlusses.
– Dranginkontinenz: Plötzlicher Harndrang, der zu unkontrolliertem Urinverlust führt.
Auch ohne Urinverlust ist «Harndrang» sehr belastend und einschränkend und muss behandelt werden. Weitere Begriffe dafür sind «Reizblase», «überaktive Blase» oder «OAB» («overactive bladder»).
Im «Blasenzentrum der Frau» wird genau abgeklärt, welche Form der Inkontinenz vorliegt, um die geeignete Therapie zu planen.
Ursachen verstehen und gezielt behandeln Geburten, hormonelle Veränderungen, Bindegewebsschwäche, Übergewicht oder chronischer Husten zählen zu den häufigsten Risikofaktoren für Belastungsinkontinenz. Bei Dranginkontinenz können unter anderem Blasenentzündungen, dünne Hautverhältnisse im Intimbereich bedingt durch den Hormonmangel nach der Menopause oder eine Reizblase ohne erkennbare Ursache eine Rolle spielen.
Sensible Diagnostik im geschützten Rahmen Ein erster Termin im «Blasenzentrum der Frau» umfasst eine ausführliche Anamnese, eine körperliche Untersuchung sowie oft ein Trink und Miktionsprotokoll. Bei Bedarf kommen BeckenbodenUltraschalluntersuchungen oder eine Blasenspiegelung zum Einsatz – alles in einer Atmosphäre, die auf Vertrauen und Diskretion basiert.
Moderne und individuelle Therapie Je nach Diagnose stehen im Blasenzentrum der Frau verschiedene Behandlungsansätze zur Verfügung:
– Konservativ: Beckenbodenphysiotherapie, Trinkund Blasentraining, Pessare, lokale Hormontherapie
Medikamentös: z. B. zur Linderung einer überaktiven Blase
Minimalinvasiv oder operativ: Schlingenverfahren, Bulking Agents oder Lasertherapie bei Belastungsinkontinenz, BotulinumtoxinInjektionen in die Blasenwand bei schwerer Dranginkontinenz
Die Therapien werden stets auf die individuelle Lebenssituation und die Wünsche der Patientin abgestimmt.
Lebensqualität zurückgewinnen
Harninkontinenz kann den Alltag massiv einschränken – von Verzicht auf Sport bis hin zu sozialem Rückzug. Ziel jeder Behandlung im «Blasenzentrum der Frau» ist es, den Betroffenen wieder Sicherheit, Bewegungsfreiheit und Lebensfreude zurückzugeben.
Früher handeln
Je früher die Diagnose gestellt wird, desto grösser sind die Chancen, die Beschwerden vollständig zu heilen oder deutlich zu lindern. Das «Blasenzentrum der Frau» versteht sich nicht nur als Behandlungsort, sondern auch als Partner in der Prävention – mit Tipps zu Beckenbodentraining, gesundem Trinkverhalten und weiteren vorbeugenden Massnahmen. Beckenbodenphysiotherapie wird ebenfalls vor Ort angeboten.
Harninkontinenz muss kein Leiden bleiben. Mit fachlicher Expertise, moderner Diagnostik und individueller Therapie bietet das «Blasenzentrum der Frau» Frauen in jeder Lebensphase eine kompetente und einfühlsame Anlaufstelle – und die Chance auf ein Leben ohne Einschränkungen.
Jetzt den ersten Schritt wagen Für viele Frauen ist der erste Schritt, über Harninkontinenz zu sprechen, der schwerste. Im «Blasenzentrum der Frau» wissen alle Mitarbeitende, wie wichtig ein respektvoller, diskreter Umgang ist. Hier dürfen Patientinnen offen über ihre Beschwerden sprechen – ohne Scham, ohne Eile, mit dem Gefühl, ernst genommen zu werden. Moderne Diagnostik, langjährige Erfahrung und eine individuell angepasste Therapie sorgen dafür, dass jede Frau eine Behandlung erhält, die zu ihr passt. So entsteht aus einem oft verschwiegenen Problem ein behandelbares Anliegen – und aus Unsicherheit wieder Selbstvertrauen.
Ziel ist es, Sicherheit, Bewegungsfreiheit und Lebensqualität in allen Lebensphasen wiederherzustellen.





Weitere Informationen unter: blasenzentrum-der-frau.ch
Praktische Tipps für die Blasengesundheit
Täglich 1,8 bis 2 Liter Wasser oder ungesüssten Tee trinken
Trink- und Miktionsprotokoll führen, um Gewohnheiten zu erkennen
Beckenbodentraining regelmässig durchführen
«Vorsorgliche» Toilettengänge vermeiden – Blasenreizende Getränke wie Kaffee oder Alkohol meiden/reduzieren

Blasenzentrum der Frau Lindenweg 7c 8500 Frauenfeld 052 / 511 20 20



































E x traCell CollaVega , Drink











E x traCell Woman, Drink Mit 30+ Nährstoffen trägt die komplette Formulierung von ExtraCellWoman zur Nervensystem, und Immun- bei: Körperfunktionen normalen der Erhaltung Knochen, Leberfunktion, Blutzuckerspiegel, Cholesterinspiegel, Fettstofwechsel, Muskeln, Energie, Haut, Bindegewebe, Haare und Nägel Aroma Beeren
Diese innovative vegane Formulierung unterstützt die Kollagenbildung, die Haut, die Haare, die Nägel, die Energie und die allgemeine Gesundheit
Diese Innovation enthält ein exklusives Reisproteinhydrolysat von höchster
Qualität, das mit spezifischen Aminosäuren angereichert ist. Eine Auswahl an Nährstoffen vervollständigt diese aussergewöhnliche Formulierung. Aroma Orange







E x traCell Beaut yCollagen, Drink


Exklusive und komplette Formulierung für Haut, Haare und Nägel

Mit Kollagenpeptiden, Aminosäuren, veganer Hyaluronsäure, veganem Glucosamin und verschiedenen Antioxidantien, Vitaminen und Mineralstoffen. Aroma Beeren und Schweizer Schokolade
E x traCell Beaut yCollagen, C aps





Komplette Beauty Kapseln mit marinem Kollagen, spezifischen Aminosäuren, Hyaluronsäure, hochwertigen Pflanzen und Pflanzenextrakten, Vitaminen und Mineralstoffen.

Diese Nahrungsergänzungsmittel sind in Apotheken und Drogerien erhältlich. ←Mehr Informationen

trägt zur Erhaltung einer normalen Gehirnfunktion und Sehkraft bei. Kapseln


Wir benutzen sie tausendfach am Tag, ohne es zu merken: unsere Hände. Sie tippen, greifen, halten, berühren – und sind doch
meist unsichtbare Begleiter. Erst wenn Schmerzen, Taubheit oder Entzündungen auftreten, wird uns ihre Bedeutung bewusst.
Ein Blick auf das unscheinbare Wunderwerk zeigt, warum wir die Hand nicht länger als selbstverständlich sehen sollten.
ie menschliche Hand ist weit mehr als ein Greifwerkzeug. Sie ist Kommunikationsmittel, Ausdrucksträger, hochpräzises Instrument und zentrales Element unseres Alltags. 27 Knochen, 36 Gelenke, mehr als 100 Bänder und Muskeln sowie ein fein verästeltes Nervensystem arbeiten perfekt zusammen, um Bewegung, Kraft und Sensibilität zu ermöglichen. Ihre Gesundheit ist daher entscheidend für unsere Lebensqualität – und zugleich anfällig für eine Vielzahl orthopädischer, neurologischer, rheumatologischer und dermatologischer Probleme. Das Fundament der Funktion
Die Hand ist ein biomechanisches Wunder. Schon kleine Störungen – etwa Sehnenentzündungen, Knochenbrüche oder Arthrosen – können die fein abgestimmte Balance empfindlich stören. Besonders häufig treten Karpaltunnelsyndrom, Sehnenscheidenentzündungen oder Arthrose im Daumensattelgelenk auf. Orthopädische Behandlungen reichen von Schienenund Physiotherapie bis hin zu gelenkerhaltenden Operationen. Ziel ist stets, Beweglichkeit und Kraft zu erhalten, um ein selbstbestimmtes Leben zu ermöglichen.
Feinfühligkeit und Präzision
Die enorme Sensibilität unserer Fingerspitzen ist einzigartig. Sie ermöglicht uns, ein Blatt Papier zu spüren oder die Temperatur einer Flüssigkeit zu prüfen. Neurologische Diagnostik und Therapien wie Neurophysiologie, Nervenschienen oder mikrochirurgische Eingriffe sind entscheidend, um Sensibilität und Bewegungssteuerung zu bewahren.
Wenn das Immunsystem angreift
Die Hand ist auch ein zentraler Ort rheumatologischer Erkrankungen. Rheumatoide Arthritis beginnt oft in den kleinen Fingergelenken, begleitet von Schwellungen, Schmerzen und Morgensteifigkeit. Entzündungen
Die Handchirurgie gehört zu den technisch anspruchsvollsten Disziplinen der Medizin.
zerstören langfristig Knorpel und Knochen. Moderne Biologie, Immuntherapien und physiotherapeutische Konzepte haben die Behandlung revolutioniert.
Dennoch bleibt eine frühzeitige Diagnose entscheidend, um irreversible Schäden zu vermeiden.
Die Hand als Werkzeug
Ob im Handwerk, in der Pflege, am Computer oder in der Musik – die Hand ist unser wichtigstes Arbeitsmittel.
Dauerhafte Belastungen können zu Überlastungssyndromen, Tendopathien oder chronischen Schmerzen führen. Auch Bildschirmarbeit birgt Risiken: Monotone Bewegungen und falsche Ergonomie begünstigen das Karpaltunnelsyndrom oder den «Mausarm». Arbeitsmedizinische Prävention umfasst ergonomische Arbeitsplatzgestaltung, regelmässige Pausen, gezielte Kräftigungs und Dehnübungen. So bleibt die Hand leistungsfähig – und ein Burnout der Sehnen wird vermieden.
Schutzschild und Spiegel der Umwelt
Die Haut der Hand ist nicht nur Schutzschicht, sondern auch unser Aushängeschild. Sie ist täglich chemischen, mechanischen und klimatischen Belastungen ausgesetzt. Ekzeme, Allergien oder chronische Hautkrankheiten wie Psoriasis können die Funktion stark einschränken. Dermatologische Prävention umfasst Handschuhe, rückfettende Pflege und UVSchutz. Gerade im medizinischen
oder handwerklichen Beruf ist Hautgesundheit ein zentrales Element der Leistungsfähigkeit.
Wenn Präzision Leben verändert
Die Handchirurgie gehört zu den technisch anspruchsvollsten Disziplinen der Medizin. Mikroskopische Operationen ermöglichen es, verletzte Nerven, Sehnen oder Gefässe wiederherzustellen, abgetrennte Finger zu reimplantieren oder durch rekonstruktive Techniken Funktion zurückzugeben. Auch nach Tumorerkrankungen, Unfällen oder schweren Infektionen kann die Chirurgie erstaunliche Ergebnisse erzielen – oft mit einer Rückkehr zu fast vollständiger Funktion. Hände gesund halten Gesunde Hände sind keine Selbstverständlichkeit – sie brauchen Pflege und Prävention.
Dazu zählen:
– Ergonomie: Richtige Haltung am Arbeitsplatz, Pausen und Bewegungsausgleich
– Training: Kräftigungsübungen für Unterarm und Handmuskulatur, Stretching gegen Versteifungen
– Pflege: Hautschutz, regelmässiges Eincremen, Handschuhe bei Chemikalien oder Kälte
– Achtsamkeit: Belastungen rechtzeitig erkennen und behandeln lassen, anstatt sie zu ignorieren
– Lifestyle: Ausgleichssportarten wie Yoga, Klettern oder Musizieren fördern Kraft, Koordination und Durchblutung der Hände
Die Hand ist ein Meisterwerk der Evolution –hochkomplex, empfindlich und unverzichtbar. Die Vielfalt medizinischer Disziplinen verdeutlicht, wie facettenreich die Hand und ihre Erkrankungen sind. Prävention, rechtzeitige Behandlung und bewusster Umgang mit unseren Händen sind entscheidend, um ihre Kraft und Präzision ein Leben lang zu erhalten.
Ein Händedruck, eine Geste oder das zarte Berühren eines geliebten Menschen transportieren Emotionen, die keine Worte brauchen. Deshalb trifft es Menschen besonders hart, wenn Einschränkungen oder Erkrankungen die Beweglichkeit oder Sensibilität ihrer Hände beeinträchtigen. Nicht selten wirkt sich dies auch psychologisch aus, da Selbstständigkeit und Ausdrucksfähigkeit unmittelbar mit der Handfunktion verbunden sind. Zugleich symbolisieren gesunde Hände Aktivität, Kreativität und Lebensfreude. Ob beim Musizieren, Malen, Kochen oder Sport – sie eröffnen uns Wege, unsere Persönlichkeit sichtbar zu machen. Wer bewusst auf Prävention und Pflege achtet, investiert nicht nur in körperliche Gesundheit, sondern auch in Lebensqualität und soziale Teilhabe. Denn die Hände sind Brücken zwischen uns und unserer Umwelt – und verdienen es, geschätzt und geschützt zu werden.
Text Aaliyah Daidi

Balance zwischen Berufsalltag und Entspannung wieder herstellen.
Hohe Anforderungen, komplexe Aufgaben, voller Terminkalender – Stress am Arbeitsplatz kann körperlich und seelisch krank machen. Immer mehr Menschen leiden deshalb unter:
Nacken-/Rückenschmerzen, Verdauungsstörungen, Kopfschmerzen,Migräne, Erschöpfung, Angst, Unruhe, Schlafstörungen, Müdigkeit,…
Nach einer Therapie bei TongTu fühlen Sie sich befreit, leistungsfähig und spüren wieder uneingeschränkte Lebensfreude. Traditionelle Chinesische Medizin (TCM) wirkt nachhaltig, natürlich und ohne Nebenwirkungen.
Rongsheng GUO

Seit 20 Jahren mit 16 Standorten in der Schweiz
Bülach
Frauenfeld
Heerbrugg
Luzern Romanshorn
St.Gallen
Thalwil
Uster
Weinfelden
Wil SG
Winterthur
Zug

Zürich beim HB
ZH-Altstetten
ZH-Höngg
ZH-Oerlikon
043 422 99 88
071 799 18 18
041 521 18 18
071 777 18 18
071 290 18 18
044 720 18 18
044 999 18 18
044 521 18 18
071 280 18 18
052 223 18 18
041 750 18 18
044 211 18 18
044 440 18 18
044 340 18 18
044 240 18 18
Vereinbaren Sie jetzt einen Termin –telefonisch oder auf www.tongtu.ch.

Sportmedizin hat sich verändert. Sie begleitet heute den gesamten Weg von der Prävention über die Diagnose bis zur Regeneration. Sie liefert individuelle Trainingspläne, hochmoderne 3DBewegungsanalysen, Kältetherapien und Kompressionsgeräte und macht es so leichter, gesund zu bleiben und nach einer Verletzung schnell wieder fit zu werden.
ie Sonne scheint, es ist Sonntagmorgen. John schlüpft in seine Funktionskleidung, die Laufschuhe sitzen perfekt. Ein Blick auf die Smartwatch: Herzfrequenz normal, Wetter ideal, Playlist bereit. Laufen ist für ihn mehr als Sport: Es ist Ritual, Freiheit, Lebensgefühl. Doch nach fünf Kilometern sticht es in der Wade. Der Schmerz bleibt. Aus dem perfekten Lauf wird eine Zwangspause. Und John beginnt nach Wegen zu suchen, wie er schnell wieder gesund werden kann.
So wie ihm geht es vielen, die regelmässig trainieren. Und genau hier setzt die Sportmedizin an. Sie ist längst nicht mehr nur für Profis da, sondern für alle, die sich gerne bewegen. Ihr Ziel ist es, Verletzungen vorzubeugen, Beschwerden zu lindern und die Freude an der Bewegung langfristig zu erhalten. Die Sportmedizin begleitet heute vom ersten Laufversuch bis zur Marathonziellinie.
Mehr als Unfallmedizin
Sportmedizin ist weit mehr als ein Besuch bei der Ärztin nach einem Sturz. Sie vereint Prävention, Diagnose, Therapie und Rehabilitation. Sportmediziner:innen betrachten den ganzen Menschen. Wie sieht das Bewegungsverhalten aus? Gibt es Fehlhaltungen oder muskuläre Ungleichgewichte? Passt das Training zum Alltag und zum aktuellen Leistungsstand?
Anders als in der klassischen Medizin geht es hier nicht nur um Heilung, sondern auch um die Optimierung von Leistungsfähigkeit und Bewegungsfreude. Oft arbeiten Ärzt:innen, Physiotherapeut:innen, Ernährungsberater:innen und Psycholog:innen Hand in Hand. Als ein Team, das körperliche und mentale Gesundheit zusammendenkt.
Prävention: lieber vorbeugen als ausfallen Die meisten Sportverletzungen sind keine
Leicht, flexibel, ergonomisch
Die Supra-Sohle bietet exzellente Dämpfung und natürlichen Bewegungs fluss. Die TPU-Lauffläche sorgt für Stabilität und Sicherheit bei jedem Schritt.

Sportmedizin ist weit mehr als ein Besuch bei der Ärztin nach einem Sturz. Sie vereint Prävention, Diagnose, Therapie und Rehabilitation.
plötzlichen Unfälle, sondern entstehen durch Überlastung. Typische Beispiele: Läuferknie, Achillessehnenreizungen, Rückenprobleme. Hier hilft die Sportmedizin, bevor es ernst wird.
Hätte John sich vor seinem Lauf einer Bewegungsanalyse unterzogen, wäre vielleicht eine muskuläre Dysbalance aufgefallen. Heute ist das Hightech: Kameras filmen den gesamten Bewegungsablauf in 3D, Sensoren messen Gelenkwinkel, Schrittlänge und Belastung. Ärzt:innen und Therapeut:innen können genau sehen, wo Fehlhaltungen entstehen und welche Muskeln nicht optimal mitarbeiten.
Auf dieser Basis entstehen präzise Trainings oder Therapiepläne. Oft mit überraschenden Erkenntnissen. Manchmal genügt eine kleine Korrektur der Lauftechnik oder ein gezieltes Krafttraining, um Beschwerden dauerhaft zu vermeiden. Gerade Freizeitsportler:innen profitieren davon: Wer Job, Familie und Training unter einen Hut bringen muss, braucht ein Programm, das sicher und effektiv ist. Das ist der Kern der Sportmedizin: lieber vorbeugen als ausfallen.
Moderne Rehabilitationsmethoden für eine schnelle Rückkehr Und wenn es doch passiert? Heute gibt es wirksame,

oft minimalinvasive Therapien. Stosswellen lösen hartnäckige Sehnenprobleme, PRPEigenbluttherapie beschleunigt die Heilung, moderne Operationstechniken verkürzen die Ausfallzeit.
Die Reha startet sofort nach der Verletzung, nicht erst, wenn der Gips ab ist. Sportmediziner:innen achten darauf, dass Patient:innen schnellstmöglich wieder in Bewegung kommen, mit Übungen, die sicher sind und den Heilungsprozess unterstützen.
Trainingspläne werden individuell zugeschnitten, abgestimmt auf Sportart, Alter und Fitnessniveau. Moderne Konzepte kombinieren Physiotherapie, Muskelaufbau, Koordination und Gleichgewichtstraining. Das stärkt nicht nur die verletzte Stelle, sondern beugt auch neuen Verletzungen vor.
Apps und Wearables dokumentieren die Fortschritte, machen sie sichtbar und steigern die Motivation. Und auch die Psyche kommt nicht zu kurz: Viele Zentren bieten mentale Begleitung an, damit die Rückkehr in den Sport nicht nur körperlich, sondern auch emotional gelingt.
Von der Kältekammer bis zur Smartwatch Sportmedizin ist technischer, zugänglicher und
alltagstauglicher denn je. Neue Forschungsergebnisse und der Trend zu mehr Bewegung haben dafür gesorgt, dass moderne Methoden längst nicht mehr nur Profis vorbehalten sind. Smartphones und Smartwatches messen Belastung, Herzfrequenz und Schlaf. Diese Daten machen uns im Alltag achtsamer und geben Ärzt:innen und Therapeut:innen wertvolle Hinweise, um Training und Erholung genau zu steuern.
Auch bei der Regeneration hat sich viel getan: Kältetherapie reicht von Eispackungen bis zu Kältekammern bei minus 110 Grad, die Entzündungen hemmen und die Erholung beschleunigen. Kompressionsgeräte massieren Beine oder Arme, regen den Lymphfluss an und lassen die Muskeln schneller regenerieren. Vibrationsmassagen lockern verspannte Muskulatur, lösen Faszienverklebungen und verbessern die Beweglichkeit. Regeneration ist damit kein passives Warten mehr, sondern ein aktiver Teil des Trainings – für ein schnelleres, sicheres Comeback. Früh handeln lohnt sich Viele warten, bis der Schmerz kaum noch auszuhalten ist und verlieren wertvolle Zeit. Wer früh reagiert, ist aber klar im Vorteil: Bei anhaltenden Schmerzen, wiederkehrenden Beschwerden oder plötzlichem Leistungsknick lohnt sich der Gang zur Sportmedizinerin. Auch John hat das gelernt. Heute lässt er seine Lauftechnik regelmässig überprüfen, trainiert gezielt seine Schwachstellen und gönnt sich aktive Regeneration. So wird jeder Sonntagmorgen wieder zu dem, was er sein soll: ein Stück Freiheit und ein perfekter Start in den Tag.
Text Sarah Steiner

Bei uns finden Sie eine breite Auswahl von mehr als 2’000 Kursen jährlich für Gross und Klein.

470 Kurse
Sportarten
Was für ein Sporttyp sind Sie? Mit der Umfrage der Uni Bern können Sie auf einfache Art Ihren Sporttyp bestimmen. In einem zweiten Schritt zeigen wir Ihnen, welche unserer Sportkurse zu Ihnen passen.
Standorte
QR-Code scannen & Umfrage starten!

Cornelia Peltenburg Co-Geschäftsführerin profawo
Diese Frage sollten sich Paare am besten schon früh stellen, denn wenn das erste Kind unterwegs ist, fällt es leichter, mit einer gemeinsamen Familienvision die nächsten Schritte zu gehen. Cornelia Peltenburg, CoGeschäftsführerin von profawo (pro family work), verrät, welche Kinderbetreuungslösungen es gibt und wie Unternehmen ihre Mitarbeitenden unterstützen können.
Frau Peltenburg, wann sollte man anfangen, über Kinderbetreuung nachzudenken?
Am besten macht man sich schon vor der Partnerwahl Gedanken darüber, ob und wie man sich eine Zukunft mit Kindern vorstellt. Im Idealfall bespricht und diskutiert man diese Zukunftsvisionen als Paar und findet eine gemeinsame Vorstellung über das Familienmodell, wie man als Eltern die Betreuungsund Erwerbsarbeit organisieren möchte. Die Suche nach geeigneten Lösungen sollte dann bereits im zweiten Drittel der Schwangerschaft beginnen.
Welche Formen der Kinderbetreuung gibt es in der Schweiz?
Die Betreuungsformen sind so vielfältig wie die Familienformen. Viele Eltern geben ihre Kinder in Krippen, aber auch Tagesfamilien sind eine beliebte Option. Dazu kommen Nannys und sehr viele private Lösungen wie Grosseltern oder anderen Verwandten oder Freunden, die in der Schweiz oft eine Alternative bieten. Je nach Wohnort und Arbeitszeiten sind nicht alle Lösungen für alle Familiensituationen geeignet.
Wie wählt man bei so vielen Möglichkeiten die beste aus? Was sind die Vor- und
PUBLIREPORTAGE
Nachteile der einzelnen Betreuungsformen?
Jede Familiensituation ist einzigartig und braucht eine Lösung, die zu ihr passt. In Kindertagesstätten steht ein ganzes Team von Fachpersonen zur Verfügung, das den Tagesablauf auf die Bedürfnisse der Kinder ausrichtet, sie mit einem pädagogischen Angebot gezielt in ihrer Entwicklung begleitet und individuell fördert. Je nach Kanton und Gemeinde können Eltern auch von subventionierten Kitaplätzen profitieren.
Auch die Betreuung in Tagesfamilien ist teilweise subventionsberechtigt. Allerdings ist man hier wie bei der Nanny auf eine einzige Betreuungsperson angewiesen, dafür sind die Betreuungszeiten oft flexibler als in einer Kita. Und da Nannys die Kinder zu Hause in der Familie betreuen, profitieren die Kinder von mehr Zeit daheim und die Eltern eventuell von der Erledigung einiger Hausarbeiten.
Auch in Ausnahmesituationen haben die verschiedenen Betreuungsformen unterschiedliche Stärken und Schwächen. So können kranke Kinder natürlich nicht in die Krippe gebracht werden und auch in Tagesfamilien ist dies zum Schutz der anderen Kinder oft schwierig. Dafür fällt in der Krippe die Betreuung nicht aus, wenn eine Betreuungsperson krank wird, wie es bei einer Tagesmutter oder einer Tagesfamilie der Fall ist. Sie sehen, jede Lösung hat ihre Vor und Nachteile. Die günstigste, aber oft auch nicht die einfachste Lösung ist natürlich die Betreuung durch Grosseltern oder Verwandte. Aber auch bei dieser Variante können Ferienabwesenheiten, Erwartungen oder auch das «Verwöhnprogramm» manchmal zumindest Nerven kosten.
Wie unterstützt profawo Eltern bei der Betreuungswahl und welche Angebote gibt es? profawo bietet unter der Marke kids & co Kindertagesstätten mit Plätzen für Kinder ab drei Monaten bis zum Kindergartenalter an. Dabei legen wir grossen Wert auf unser pädagogisches Konzept nach dem Motto «professionelle Pädagogik – liebevoll umgesetzt». Darüber hinaus vermitteln wir Nannys und «wenn alle Stricke reissen» springen unsere erfahrenen Notnannys ein. Bei den Einsätzen handelt es sich nicht immer um Notfälle, sondern
auch um kurzfristige Entlastungen bei Arztterminen oder beruflichen Verpflichtungen der Eltern. Nicht zuletzt bieten wir auch ein Ferienprogramm an, das den Kindern viel Spass und Freude bereitet und die berufstätigen Eltern entlastet – denn wer hat schon 13 Wochen Ferien?
Bei all diesen Möglichkeiten können Eltern schnell überfordert sein, deshalb bieten wir auch eine persönliche Beratung an. Wir helfen, die beste Option für die spezifischen Bedürfnisse der Familie zu finden. Oft helfen wir auch Expats, sich im Schweizer Schul und Betreuungssystem zurechtzufinden.
Jede Familiensituation ist einzigartig und braucht eine Lösung, die zu ihr passt.
– Cornelia Peltenburg, Co-Geschäftsführerin profawo
profawo unterstützt nicht nur Eltern, sondern auch Unternehmen. Wie kann man sich das vorstellen? profawo unterstützt Unternehmen sowohl direkt auf dem Weg zum familienfreundlichen Arbeitgeber als auch indirekt durch Lösungen und Angebote für die Mitarbeitenden. Wenn wir Mitarbeiter:innen gut beraten und ihnen gute, stabile und flexible Betreuungslösungen anbieten, arbeiten sie konzentrierter, motivierter und sind weniger gestresst. Die Kombination aus beidem macht unser Angebot so einzigartig. Wir unterstützen die Mitarbeitenden unserer Mitgliedsunternehmen direkt mit einer breiten Palette von Angeboten, um gute, stabile und flexible Lösungen zu finden. Neben Betreuungs und Beratungsangeboten
bieten wir auch verschiedene Onlinesessions zu Vereinbarkeitsthemen an. Themen wie Familienfinanzen, Familienmodelle, Tipps und Tricks zur Familienorganisation, Teilzeitväter, Informationen zum Schweizer Schulsystem oder auch Patientenverfügung und Selbstfürsorge bei der Betreuung von Angehörigen sind aktuelle Beispiele aus unserem breiten Angebot. Diese für die Mitarbeitenden der Mitgliedfirmen kostenlosen «LunchVeranstaltungen» ergänzen das Weiterbildungsangebot unserer Mitgliedfirmen in idealer Weise. Die Mitarbeitenden der Mitgliedsfirmen profitieren von kostenlosen und vergünstigten Angeboten – das Dienstleistungsangebot der profawo steht aber allen zur Verfügung.





Über profawo
Seit 1996 fördert profawo (pro family work) die Vereinbarkeit von Familie und Beruf. Der NonProfit-Verein bietet ein breites Dienstleistungsangebot im Bereich der familienergänzenden Kinder- und Angehörigenbetreuung. Im Zuge der sich ständig wandelnden Anforderungen in der Arbeitswelt entwickelt profawo stetig neue Konzepte und Angebote rund um die Vereinbarkeit von Familie und Beruf. Die Werte Vertrauen, Professionalität, Gesundheit und Nachhaltigkeit bilden dabei das Fundament der Arbeit mit Kindern, Eltern, betreuenden Angehörigen und Mitarbeitenden.
Weitere Informationen unter: www.profawo.ch

Seit Jahren unterstützt das Zahnmännchen Familien für gute Mundgesundheit. Nun erweitert es seine Mission: Mit Zahnrettungsboxen sorgt es dafür, dass Kinder auch im Notfall ihr Lachen behalten können.

Eltern wissen: Zähneputzen mit Kindern ist nicht immer ein «Kinderspiel». Genau hier unterstützt das Zahnmännchen von Aktion Zahnfreundlich Schweiz. Es zeigt Kindern in Schulen, wie Zahnpflege Spass machen kann, erklärt die Bedeutung gesunder Snacks und sorgt so spielerisch für gesunde Zähne.
Doch das Zahnmännchen denkt weiter. Im Sommer 2025 brachte Aktion Zahnfreundlich Schweiz Zahnrettungsboxen in die Schulen – ein landesweit einzigartiges Projekt, das zusätzliche Sicherheit schafft. Die Box enthält eine spezielle Nährlösung, die ausgeschlagene Zähne bis zu 30 Stunden frisch hält. So bleibt genug Zeit, damit Zahnärzt:innen den Zahn oft noch retten können.
Zahnrettungsboxen – ein Projekt von Aktion
Zahnfreundlich Schweiz
Das Zahnmännchen steht damit nicht nur für Prävention, sondern auch für konkrete Hilfe im Ernstfall. Eltern und Lehrpersonen können sich darauf verlassen: Wir sind vorbereitet. Und Sie? Sprechen Sie Ihre Schule auf die Zahnrettungsbox an –für gesunde Zähne und fröhliche Kinder.
Mehr Infos auf unserer Webseite: zahnfreundlich.ch/ zahnrettungsboxen


Er kommt aus der Luxushotellerie und führte bis 2010 das Grand Hotel Bellevue (nun unter dem Namen Le Grand Bellevue) in Gstaad. Heute betreibt Michel Wichman –zusammen mit Ilse – das Hotel Spitzhorn in SaanenGstaad, das zum vierten Mal in Folge im grossen Hotelrating der Sonntagszeitung als «Bestes Winterhotel der Schweiz» in der DreisterneKategorie gekürt wurde. Wichman ist auch Gründungsmitglied und ehemaliger Präsident des Vereins «Best 3 Star Hotels of Switzerland».
Herr Wichman, verraten Sie uns Ihr Erfolgsrezept? (lacht)...Ich werde Ihnen an dieser Stelle natürlich nicht unser ganzes Betriebskonzept verraten, aber unser Ziel war es immer, auf Understatement zu setzen. Die Antwort zu dieser Frage ist wahrscheinlich genauso vielschichtig, wie die persönliche Definition von Erfolg selbst. Man muss hart dafür arbeiten. Es ging uns auch darum, mit den investierten Mitteln, bevorzugt langjährig, eine normale Rendite zu erzielen. Wir sind nicht in der Lage, schauen Sie sich gewisse FünfsterneHäuser an, viele Millionen zu investieren um schlussendlich zu konkludieren, dass die Rendite fehlt. Gstaad hatte auch damals schon viele wunderschöne Fünf und ViersterneHäuser. Für uns war klar, dass ein gutes, bodenständiges DreisterneHotel der Region einen Mehrwert geben würde. Es ging uns darum, die Erwartungen der Gäste, eingestuft von einem Dreisternekonzept, zu übertreffen. Unsere Gäste sollten denken: «Wow, was für ein tolles Haus!» Mit Ihrer Philosophie «die Leichtigkeit des Seins» ermutigen Sie die Gäste den Alltag hinter sich zu lassen. Wie gelingt Ihnen das? Wir leben in einer komplexen Zeit: Unser Leben scheint sich zunehmend zu beschleunigen, getrieben durch digitale Technologien. Mobile Devices und Laptops sind Teil unseres Lebens geworden, wodurch es uns zunehmend schwerer fällt abzuschalten. Ja, es fehlt uns an Zeit und Raum, Stille und Klarheit. Ein begeisterter Gast hat das Saanenland einmal mit der Harmonie einer schönen Melodie verglichen: Nichts ist übertrieben, alles atmet stille Schönheit in Grün für die Wiesen und Wälder, in Blau für Seen und Himmel, in Weiss für Wolken und Schnee. Man steht da und geniesst, umringt von einem Kranz hochragender Berge. Einer der schönsten trägt den Namen Spitzhorn. Er ist ein Schönwetterberg und teilt die Wolken. Daran orientiert sich unser Hotel. Wer hier eintritt, lässt die Eile und die Hektik des Alltags hinter sich. Der Aufenthalt im Spitzhorn soll die Gäste so sehr verzaubern, dass sie sich aufs Wiederkommen freuen. Luxus ist immer weniger in Dingen zu finden, sondern häufiger in Erlebnissen, die uns aus unserem Alltag herausheben, vielleicht eine Familie zusammenführen, einen Horizont erweitern oder ein Gefühl von Freiheit vermitteln. All dies mit dem Wissen, einfach entspannen zu können, weil sich jemand um alles kümmert.
Sie betonen stets, dass Ihnen Kundenbewertungen wichtiger sind als die klassische Sterneklassifizierung. Wie pflegen
Sie den Kontakt zu Ihren Gästen online?
Sterne an sich sind für das Spitzhorn irrelevant. Portale für OnlineBewertungen hingegen sind ein sehr wichtiges Mittel. Durch diese Portale erhalten wir jeden Tag aufs Neue Sternebewertungen von unseren geschätzten Gästen. Doch es braucht beides: Hotelsterne, beziehungsweise Klassifizierungen, und Gästebewertungen. Die Sterne bieten dem Gast eine Orientierung. Sie sind die Basis und das wird auch so bleiben. Andererseits werden Onlinebewertungen und SocialMediaKanäle immer wichtiger. Als Hotelier muss man voller Elan dabei sein!
Man sagt, dass Schweizer Hoteliers den «Hype» Social Media verschlafen, respektive erst spät erkannt haben. Worin sehen Sie die Vorteile einer aktiven Online-Strategie?
Nach endlosen Wochen nervenzehrender Arbeit hat man Ferien reichlich verdient. Richtige Ferien, wahre Ferien. Wo, wie, wann? Das ist die Nuss, die es zu knacken gilt. Wer die Nussschale sprengt, muss auf Gastgeber aus Leidenschaft stossen. Auf Menschen, welche das Gastgeben zum Beruf gewählt haben und sich in dieser Rolle jeden Tag neu erfinden damit sie nie in Routine erstarren. Das Internet ist das ideale Kommunikationsmittel dafür. Unser Sohn Moritz hat bereits viele positive Erfahrungen vor und während sowie nach dem Bau, mit uns und dem Spitzhorn erleben können. Besonders, dass hinter allem viel harte und vor
Nicht immer mehr von allem, sondern das Beste vom Wichtigen.
– Michel Wichmann, Gastgeber und Pächter des Hotels Spitzhorn in Saanen BE
allem schöne Arbeit steckt. Auf unserer Website haben wir dieses Insiderwissen von Moritz, dem jüngsten Gastgeber des Chalethotels Spitzhorn, in einem Video festgehalten. Richtig genutzt, ist Social Media sowohl diskret wie auch persönlich.
Was dürfen Familien mit Kindern bei Ihnen im Spitzhorn erwarten? Wir bieten unseren Gästen zum Beispiel einen Innenpool an, was die meisten Dreisternehäuser nicht haben. Oder denken Sie an unseren einfachen, aber schönen Wellnessbereich mit Sauna, Dampfbad und Fitnessraum, Sportshop im Hotel, Kinderspielzimmer und Aussenspielplatz. Hinzu kommt die hochwertige Ausstattung der Zimmer und Räume. Aber noch viel wichtiger ist die Software. Umfragen bestätigen immer wieder, dass sich unsere Gäste (ob

gross oder klein) erst wohl fühlen, wenn sie sehen und gesehen werden. Das eigentliche Produkt, nämlich die Speisen und Getränke, treten dabei völlig in den Hintergrund. Unsere Gäste bezahlen für nichts so viel, wie für die sogenannten weichen Faktoren und die haben mit Ambiente, Gefühle, Farben, Fantasien, Emotionen und Wohlbefinden zu tun. Sie bezeichnen sich und Ihr Team als «Serving People». Wie treiben Sie Ihr Team zu Höchstleistungen an?
Das Geheimnis liegt in einem wertschätzenden Arbeitsfeld, in dem Spiel, Freude, Lust und Spass, Konzentration und engagierte Mitarbeiter für mehr Energie, Begeisterung und höhere Produktivität sorgen. Qualität statt Quantität heisst auch, dass viel Personal nicht immer gleichzeitig auch Qualität bedeutet. Perfekte «Serving People» strahlen eine gewisse Leidenschaft für ihre Aufgabe aus. Das sehen wir und sieht der Gast in strahlenden Gesichtern, kluger Dienstleistung und TopQualität. Weiterhin sind wir davon überzeugt, dass die Tatsache, zu wissen für wen man arbeitet, für die Mitarbeiter ein nicht zu unterschätzender Identifikations und Motivationsfaktor sein kann. Die Mehrheit der Mitarbeiter bleiben uns und dem Hotel Spitzhorn auch nach fünf Jahren treu. Warum sollten die Leute eigentlich ins Saanenland reisen?
Wir befinden uns hier auf der wunderschönen Wintergarten Terrasse; umringt von einem Kranz hochragender Berge. Einer der schönsten trägt den Namen «Spitzhorn». Lassen Sie einfach mal Ihren Blick herumschweifen, über die wunderschöne Umgebung, die prachtvolle Natur. Viele Leute bezahlen viel Geld, um hier im Saanenland zwei Wochen Ferien machen zu können. Wir haben das Privileg, sogar das ganze Jahr hier wohnen und leben zu dürfen. Was mir am Saanenland besonders gefällt, ist die hohe Lebensqualität. Ein Dorf ohne Verkehrsampeln, ohne Stau, mit ebenso vielen Kühen wie Einwohnern. Ein kleines Dorf, das aber trotzdem sehr international ist. Qualität statt Quantität. Saanen Gstaad – my love
Text Juan Paulo Zenz
Bilder Hotel Spitzhorn
Weitere Informationen und Buchungen unter: www.spitzhorn.ch

ie moderne Medizin erlebt derzeit einen bemerkenswerten Wandel, bei dem innovative Therapieansätze zunehmend in den Vordergrund rücken. Ein vielversprechender Bereich, der sowohl Forscher:innen als auch Mediziner:innen in der Schweiz fasziniert, ist die Stammzellenbehandlung – auch bekannt als Zellbehandlung. Diese Technologie birgt das Potenzial, zahlreiche Erkrankungen und Verletzungen zu behandeln, die bislang nur schwer oder gar nicht heilbar waren. Was sind Stammzellen?
Stammzellen sind besondere Zellen, die sich in verschiedenen Zelltypen des Körpers entwickeln können. Sie haben die Fähigkeit, sich unbegrenzt zu teilen und sich zu spezialisieren, wodurch sie beschädigtes Gewebe regenerieren oder ersetzen können. Es gibt verschiedene Arten von Stammzellen: embryonale Stammzellen, adulte Stammzellen und induzierte pluripotente Stammzellen (iPSZellen).
Die Einsatzmöglichkeiten
In der Schweiz wird die Stammzellenbehandlung vor allem in der regenerativen Medizin eingesetzt. Typische Anwendungsbereiche sind:
1. Orthopädie: Die Behandlung von Gelenkbeschwerden, Arthrose und Sportverletzungen profitiert erheblich von der regenerativen Kraft der Stammzellen. Patient:innen berichten häufig von einer Linderung der Schmerzen sowie von einer verbesserten Beweglichkeit.
In der Schweiz sind die Voraussetzungen dafür geschaffen: Mit einer exzellenten Forschungslandschaft, hoch qualifizierten Fachärzt:innen und modernsten medizinischen Einrichtungen bleibt das Land ein Vorreiter in der Entwicklung und Anwendung von Zelltherapien.
2. Neurologische Erkrankungen: Studien weisen auf vielversprechende Fortschritte in der Therapie von neurodegenerativen Erkrankungen wie Parkinson, Multipler Sklerose und Schlaganfällen hin.
3. Autoimmunerkrankungen: Stammzellen können das Immunsystem modulieren und somit bei Erkrankungen wie rheumatoider Arthritis oder Lupus eingesetzt werden.
4. Ästhetische Medizin: Auch im AntiAgingBereich, der Hautverjüngung und dem Haarwachstum kommen Stammzellen zunehmend zum Einsatz.
Wie funktioniert die Stammzellenbehandlung?
Der Ablauf einer Stammzellenbehandlung variiert je nach Erkrankung und eingesetztem Zelltyp. Meist werden den Patient:innen körpereigene Stammzellen entnommen – oft aus Fettgewebe (adipöse Stammzellen) oder Knochenmark – und anschliessend aufbereitet. Danach werden sie gezielt in das betroffene Areal injiziert oder systemisch verabreicht. Die Zellen unterstützen den Heilungsprozess, indem sie beschädigtes Gewebe regenerieren und Entzündungen hemmen.
Die Vorteile einer Zellbehandlung
Die Stammzellenbehandlung zeichnet sich durch mehrere Vorteile aus:
– Minimalinvasiv: Viele Anwendungen kommen ohne Operation aus. – Körpereigen: Die Verwendung eigener Zellen minimiert Abstossungsreaktionen und Komplikationen.
– Nachhaltige Wirkung: Stammzellen können nicht nur Symptome lindern, sondern Heilungsprozesse anstossen.
Regulierung und Forschung in der Schweiz In der Schweiz unterliegt die Anwendung von Stammzellen strengen gesetzlichen Bestimmungen. Das Schweizer Heilmittelinstitut Swissmedic spielt hierbei eine zentrale Rolle. Es trägt Sorge dafür, dass Therapien sicher und ethisch vertretbar sind. Nur spezialisierte Kliniken und Ärztinnen und Ärzte dürfen Zelltherapien anbieten.
Die Forschung in der Schweiz ist umfassend und von hoher Anerkennung. Schweizer Universitäten
und Kliniken arbeiten eng zusammen, um neue Therapien zu entwickeln und deren Wirksamkeit wissenschaftlich zu belegen. Zahlreiche klinische Studien laufen, um den Einsatz der Stammzellen bei Herzinfarkten, Diabetes, Querschnittslähmung oder auch Alzheimer weiter zu erforschen.
Herausforderungen und ethische Aspekte Trotz der vielversprechenden Chancen bestehen auch Herausforderungen. Die genaue Wirkungsweise von Stammzellen wird noch nicht vollständig verstanden. Risiken wie unkontrolliertes Zellwachstum oder unerwünschte Nebenwirkungen müssen sorgfältig beobachtet werden. Besonders der Einsatz embryonaler Stammzellen ist ethisch umstritten und in vielen Ländern, einschliesslich der Schweiz, stark reguliert. Transparenz, Aufklärung und ethische Verantwortung sind daher von zentraler Bedeutung. Patient:innen sollten sich vor einer Behandlung ausführlich beraten lassen und auf zertifizierte Einrichtungen achten.
Zukunftsaussichten
Die Stammzellenbehandlung steht an der Schwelle zu einem medizinischen Durchbruch. In den kommenden Jahren wird erwartet, dass immer mehr evidenzbasierte Therapien entwickelt werden, die das Leben von Patientinnen und Patienten nachhaltig verbessern können. Besonders in der personalisierten Medizin wird die Zellbehandlung eine entscheidende Rolle spielen. In der Schweiz sind die Voraussetzungen dafür geschaffen: Mit einer exzellenten Forschungslandschaft, hoch qualifizierten Fachärzt:innen und modernsten medizinischen Einrichtungen bleibt das Land ein Vorreiter in der Entwicklung und Anwendung von Zelltherapien.
Die Stammzellenbehandlung bietet neue Hoffnung für Patient:innen mit bislang schwer behandelbaren Erkrankungen. In der Schweiz wächst dieser medizinische Bereich kontinuierlich und profitiert von einem fortschrittlichen Gesundheitssystem, innovativer Forschung und einem hohen ethischen Standard. Obwohl weitere Studien notwendig sind, um die langfristige Sicherheit und Wirksamkeit zu bestätigen, zeigt sich bereits heute: Die Zukunft der Medizin ist regenerativ – wobei Stammzellen eine bedeutende Rolle einnehmen. Wenn Menschen nach Lösungen suchen, die Hoffnung schwindet und alternative Therapien nicht erfolgreich sind, bieten Stammzellen neue Möglichkeiten. Sie repräsentieren das menschliche Bestreben, Schmerzen zu verringern und die Lebensqualität zu verbessern. Hinter jeder Zelltherapie verbirgt sich die Erwartung auf ein gesünderes und erfüllteres Leben – und genau dieser Antrieb der Hoffnung motiviert Wissenschaftler:innen und Mediziner:innen weltweit.
Text Aaliyah Daidi

Bad Ragaz ist seit Jahrhunderten ein Sehnsuchtsort für Heilung, Erholung und Regeneration. Bereits im 13. Jahrhundert wurde die TaminaQuelle entdeckt – ein Geschenk der Natur, das Menschen bis heute Kraft, Balance und Vitalität schenkt. Nun schlägt das Grand Resort Bad Ragaz ein neues Kapitel auf: Am 1. Oktober 2025 eröffnet das Tamina Health Center, ein weltweit führendes Kompetenzzentrum für präventive Medizin, Longevity und ganzheitliche Gesundheit.

Unter der Leitung von Dr. med. Alexandra Dopplinger vereint das Tamina Health Center modernste Diagnostik und medizinische Exzellenz mit der jahrhundertealten Tradition des heilenden Thermalwassers. Über 100 Fachärzte, Therapeuten und Spezialisten arbeiten Hand in Hand, um Gäste auf ihrem Weg zu einem längeren, gesünderen und erfüllteren Leben zu begleiten.
Das Geheimnis liegt im Wasser
Die TaminaQuelle, tief verborgen in der gleichnamigen Schlucht, ist das Herzstück von Bad Ragaz. Ihr 36,5 Grad warmes Thermalwasser ist sanft und doch kraftvoll in seiner Wirkung. Es füllt nicht nur die berühmten Thermen, sondern fliesst in ausgewählten Zimmern sogar direkt aus dem Wasserhahn.
Seit Jahrhunderten gilt dieses «Blaue Gold» als Quelle von Heilung und Jugendlichkeit. Heute bildet es die Basis vieler Therapien im neuen Tamina Health Center: von klassischen Kuren bis hin zu innovativen Anwendungen, die Wasser, Wärme und moderne Wissenschaft vereinen. «Das Wasser ist unser Ursprung – und unsere Zukunft», sagt Dr. Dopplinger. «Wir verbinden seine Heilkraft mit neuesten Erkenntnissen aus LongevityForschung und Präventivmedizin.»
Vier Säulen für ein gesundes Leben Das Konzept des Tamina Health Centers basiert auf vier Grundpfeilern, die für ein langes und vitales Leben entscheidend sind: – Bewegung – von gezieltem Training bis zu sanften Mobilisationsprogrammen
– Ernährung – individuell abgestimmt, wissenschaftlich fundiert
– Schlaf – Regeneration für Körper und Geist – Mentale Gesundheit – innere Balance, Resilienz und Klarheit
Unser Ziel ist es nicht, das Alter aufzuhalten. Unser Ziel ist es, das Leben mit mehr Energie, mehr Freude und mehr Qualität zu füllen. Das Tamina Health Center macht genau das möglich.
– Dr. med. Alexandra Dopplinger
«Wir stehen für einen Paradigmenwechsel», so Dr. Dopplinger. «Wellness ist nicht mehr nur Verwöhnung – es ist eine Investition in die Zukunft. Wir wollen unseren Gästen ermöglichen, nicht nur länger zu leben, sondern besser.»
Gesundheit im Luxusrahmen
Das Grand Resort Bad Ragaz bietet dafür den passenden Rahmen: vier Grand Hotels, sieben Restaurants mit insgesamt sechs MichelinSternen und unzählige Möglichkeiten für Bewegung und Kultur. Wer hierherkommt, erhält nicht nur ein medizinisches Gesundheitsprogramm, sondern ein Gesamterlebnis – zwischen Golfplatz, Kunst, Kulinarik und der stillen Kraft der Natur.
Jeder Aufenthalt beginnt mit umfassenden diagnostischen Tests, darunter zum Beispiel epigenetische Tests, Herzratenvariabilität, Laboranalysen oder MikrobiomProfile. Die Ergebnisse bilden die Grundlage für hoch personalisierte Programme, die nicht nur während des Aufenthalts wirken, sondern auch in den Alltag integriert werden können.
Fünf Programme für individuelle Ziele
Die Angebote des Tamina Health Centers decken zentrale Bedürfnisse einer modernen, gesundheitsbewussten Gesellschaft ab:
Longevity (3–14 Tage): SignaturProgramm zur biologischen Verjüngung, Zellregeneration und Stärkung der Leistungsfähigkeit –
Detox (7 Tage): Medizinisch geführte
Entgiftung für ein starkes Immunsystem und einen klaren Stoffwechsel
– Weight Loss (7–13 Tage): Gewichtsmanagement
mit Fokus auf Hormonbalance und metabolische Flexibilität
– Recharge (3–5 Tage): Tiefenentspannung und Stressregeneration mit modernen wie traditionellen Methoden
– Health Check-up (3–4 Tage): Präventive Diagnostik mit modernster Medizintechnik
Ergänzt werden die Programme durch modernste zubuchbare Leistungen und Therapien wie beispielsweise hyperbare Sauerstoffbehandlung, Infusionstherapien oder IntervallHypoxieHyperoxieTherapie.
Tradition trifft Zukunft
Das Besondere am Tamina Health Center ist die Balance von Geschichte und Moderne. Während draussen die Natur mit Thermalwasser, Bergen und Wäldern heilt, setzen Ärzte und Therapeuten im Innern auf modernste Technologien, um Alterungsprozesse zu verlangsamen.

Die Neuausrichtung der Medizin ist Ausfluss der unter der Leitung von CEO Dr. Klaus Tschütscher ausgearbeiteten und vom Verwaltungsrat genehmigten «ResortStrategie Grand Resort Bad Ragaz 2035» mit Fokus auf den Bereich von Health & Wellbeing.

The Art of Growing Younger
Mit dem Tamina Health Center festigt das Grand Resort Bad Ragaz seine Position als eine der weltweit führenden Adressen für Gesundheit und Longevity. Hier wird das Alter nicht gefürchtet, sondern gefeiert – als Chance, das Leben bewusster, gesünder und schöner zu gestalten.
Die Verbindung von Tradition, Natur und Wissenschaft macht Bad Ragaz einzigartig. Wer das Resort besucht, entdeckt nicht nur die Kunst des Entspannens, sondern die Kunst, jünger zu werden.
Weitere Informationen unter: resortragaz.ch